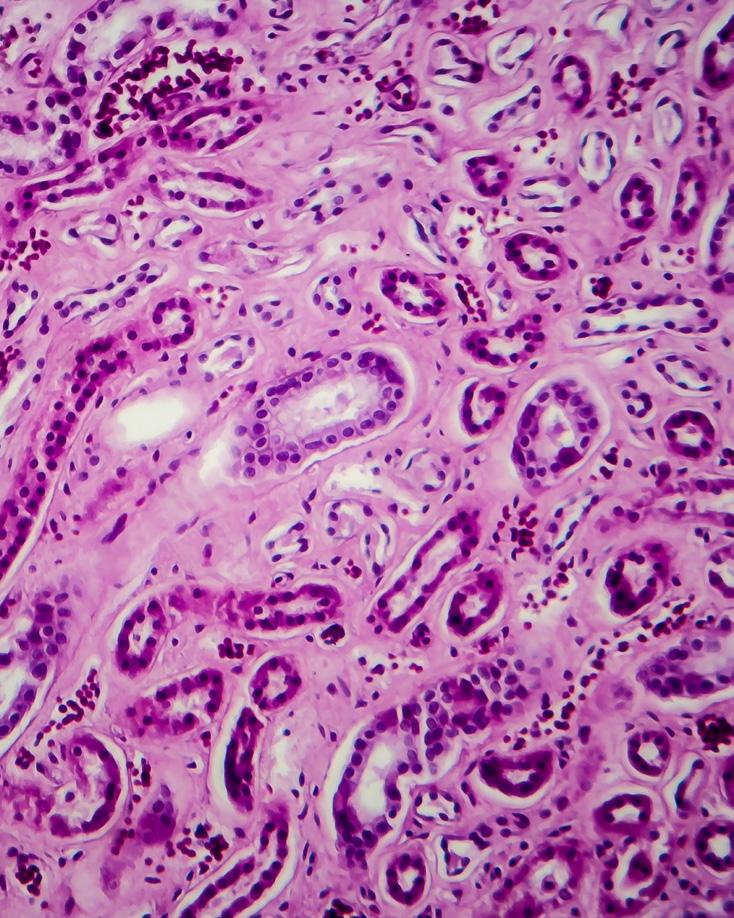

SHAPING the FUTURE of INNOVATION










![]()


















Hugh Roy and Lillie Cranz Cullen Distinguished University Professor and Dean
Pradeep Sharma
Senior Associate Dean for Research and Facilities
Dmitri Litvinov
Senior Associate Dean for Graduate Programs and Computing Facilities
Suresh K. Khator
Senior Associate Dean for Undergraduate Programs and Distance Learning
JR Rao
Senior Associate Dean for the Technology Division
Heidar Malki
Associate Dean for Academic Affairs for the Technology Division
Ron Hopkins
Associate Dean for Student Success and Undergraduate Support Services
Jamison V. Kovach
PARAMETERS
Parameters is published biannually by the University of Houston's Cullen College of Engineering, Office of Communications.
Executive Director of Communications
Inez Hutchinson
Communications Manager
Hunter Corfield
Program Manager II
Shandolyn Arline-Johnson
Graphic Designers
Olga Medrano
Ruchita Patel
Communications Coordinator
Alex Keimig
Senior Writer/Editor
Stephen Greenwell
Contributing Writers and Editors
Laurie Fickman | Rashda Khan
John Lienhard | Bryan Luhn
Alison Medley | Ashley V. Velazquez
Stock imagery provided by iStock, Pexels, Shutterstock, Unsplashed and Freepik
Contact us:
University of Houston
Cullen College of Engineering
Office of Communications Engineering Building 2
4222 Martin Luther King Blvd, Suite E311 Houston, Texas 77204-4009
The University of Houston is an Equal Opportunity/Affirmative Action institution. Minorities, women, veterans and persons with disabilities are encouraged to apply.
Those wishing to reprint articles or photographs should contact the director. Use the credit line: Reprinted with permission of the University of Houston Cullen College of Engineering. Clippings are appreciated.
Biomedical Engineering Chairman: Metin Akay www.bme.uh.edu 832-842-8813
Chemical & Biomolecular Engineering
Chairman: Triantafillos (Lakis) Mountziaris www.chee.uh.edu 713-743-4300
Civil & Environmental Engineering
Chairman: Roberto Ballarini www.cive.uh.edu 713-743-4250
Construction Management
Interim Chairman: Ahmed Senouci www. dot.egr.uh.edu/departments/cm 713-743-6131
Electrical & Computer Engineering
Interim Chairman: Ji Chen www.ece.uh.edu 713-743-4400
Engineering Technology Chairwoman: Fatima Merchant www.dot.egr.uh.edu/departments/et 713-743-8292
Human Development & Consumer Sciences Chairwoman: Barbara Stewart www.dot.egr.uh.edu/departments/hdcs 713-743-4119
Industrial Engineering Chairman: Gino J. Lim www.ie.uh.edu 713-743-4180
Information Science Technology
Interim Chariman: George Zouridakis www.dot.egr.uh.edu/departments/ilt 713-743-6405
Mechanical & Aerospace Engineering Chairman: Karolos Grigoriadis www.me.uh.edu 713-743-4500
Petroleum Engineering
Interim Chairman: Dimitrios G. Hatzignatiou www.petro.uh.edu 832-842-4848
Office of Advancement
Mail: University of Houston Cullen College of Engineering Engineering Building 2 4222 Martin Luther King Blvd, Suite E421 Houston, Texas 77204-4007
Attn: Margarita Frinsco advancement.egr.uh.edu













When I reflect on the incredible strides we’ve made in innovation and the groundbreaking inventions that have transformed our world, I am filled with awe and pride. At the Cullen College of Engineering, we are not just part of this evolution; we are driving it forward, shaping the future with every breakthrough and discovery.
In this issue, we are highlighting the remarkable work happening within our community. Each page tells a story of progress and vision, highlighting how our collective efforts are paving the way for a brighter future.
We begin with an exciting exploration of "The Future of Aerospace in Space City." Houston's status as a burgeoning aerospace hub is no accident. Our college’s innovative research and visionary projects are setting new benchmarks in space exploration. From developing cutting-edge technologies to forging pivotal partnerships, our work is not only advancing the field but also establishing Houston as a leader on the global stage.
Next, we delve into "Innovating the Road to Student Success." Our commitment to transforming the student experience is evident in the creative programs and strategies we are implementing. By integrating personalized learning approaches, robust mentorship, and supportive resources, we are empowering our students to achieve their fullest potential. Our focus is on nurturing talent and preparing the next generation of engineers to meet the challenges of an ever-evolving world.
Finally, we highlight "Climate Smart Biotech," showcasing how our groundbreaking research is addressing some of the most pressing environmental issues of our time. Our engineers and scientists are at the forefront of developing sustainable biotech solutions that not only drive progress but also contribute to a healthier planet. This work reflects our dedication to innovation that harmonizes with our commitment to environmental stewardship.
As I look at the work being done by our faculty, students, and alumni, I am continually inspired. Your passion, creativity, and dedication are what make Cullen College of Engineering a beacon of innovation. Together, we are not just imagining the future; we are creating it.
I hope you find this issue as inspiring and exciting as I do, and that it ignites in you the same sense of possibility and potential that fuels our work every day.
Sincerely,

Pradeep Sharma Dean of the Cullen College of Engineering
Hugh Roy and Lillie Cranz Cullen Distinguished University Professor



Nocedal Northwestern University

Meneveau John Hopkins University
Yannis Yortsos University of Southern California
For the more information on our engineering conversations, visit erg.uh.edu/our-college/rockwell-lecture
BY STEPHEN GREENWELL
A look back at past stories and interview subjects, and what those Cougars are up to now...



The alumni spotlight was on Jim Kaucher, then the vice president of Tech Services & Supply Chain Management at Cheniere Energy, Inc. A Mechanical Engineering graduate from Cullen, he spent 30 years at M.W. Kellogg, which was renamed KBR following a merger in 1998. His work with LNG was highlighted as a way to explain the burgeoning market for that form of fuel. According to the International Group of Liquefied Natural Gas Importers, trading of LNG was first measurable in 1971, at a rate of 2.6 million tons. In 2000, this was still relatively low by the scope of the global energy market at 96.24 MT, but this swelled to 239.18 by 2013. In 2023, trading of LNG reached a new peak of 401 MT. Kaucher retired in May 2016, and lives in the Houston metro area with his wife, Lynn. The couple established the Jim and Lynn Kaucher Endowed Scholarship to support undergraduate students in the greater Houston area.
The Cullen College of Engineering was gearing up to be one of the prominent programs involved with the launch of the University of Houston at Katy. The Katy campus offers students an “engineering academy,” which allows students to be enrolled concurrently at the nearby Houston Community College and UH. As long as students meet all course and GPA requirements at HCC, they can seamlessly transition into pursuing an engineering degree at Cullen without going through the formal transfer process. Now several years into the development of the Katy campus, the first cohort of students have graduated with their engineering degrees.



Metin Akay and Abdeldjelil “DJ” Belarbi joined the faculty of the Cullen College of Engineering, in the Biomedical and Civil & Environmental engineering departments, respectively. Both remain at the college to this day. Akay is the founding chairman of his department. Recently, he received several honorary degrees from international universities. and he is one of 50 top scientists to publish a roadmap for groundbreaking research to transform the landscape of medicine in the coming decade.





The Cullen College of Engineering produced its first ever video for this edition of Parameters. Available in the Quicktime format, the six-minute presentation features interviews with Raymond W. Flumerfelt, dean of the college at the time, voiceover narration from John Lienhard, and interviews with professors like Stuart Long. It was produced by Harriet Yim, who remains with the college's communications office. Visit our YouTube account to see some great visuals from the past featured in this video!



Shortly after the tragic collapse of the Key Bridge in Baltimore, Dr. Vedhus Hoskere, an assistant professor of Civil & Environmental Engineering at the University of Houston, sat down with Fox 26 to discuss the role of bridge inspections, the need for better pier protection systems, bridges in the Houston area, and how his recent research on developing digital twins might help.
READ ONLINE AT: https://www.linkedin.com/posts/vedhushoskere_sharing-some-ofmy-thoughts-on-the-tragic-activity-7178792451376078848-To1J?utm_ source=share&utm_medium=member_ios
For several weeks, ABC13 Meteorologist Elyse Smith covered how the City of Houston manages recycling, specifically looking at how plastic is recycled. Megan Robertson sat down with Eyewitness News to discuss mechanical recycling. This is a process where recycling is sorted to separate the plastic. Then, the plastic is chopped, melted in an extruder, and shaped in an injection molder. While the process does make plastic recyclable, sometimes the quality of the plastic can be impacted. Robertson went on to explain that recycling plastic is harder than it looks because of how many different kinds of plastic there are.
READ MORE ONLINE AT: https://abc13.com/post/mechanical-recycling-ways-to-recycle-plastic-university-of-houston-lab-process-sorting-facilities/14813943/


Birol Dindoruk, a professor of petroleum engineering at the University of Houston, was featured in an Associated Press article discussing how New York updated its fracking ban to include liquid carbon dioxide and water.
VIEW ONLINE AT:
https://apnews.com/article/carbon-dioxide-fracking-new-york-drilling-3a062e57c55f2a5be53da5d58e1d3698


EVs can only be as green as their power grid. KPRC 2 sat down with Dr. Harish Krishnamoorthy, associate professor of electrical and computer engineering and a Houston area expert, to learn how green the Texas grid is. Krishnamoorthy shared that the Texas power grid is very green, and in comparison, an EV from manufacturing to the end of its life cycle will emit 18 tons. While the difference might seem small now, with continuous improvements in battery production for EVs, CO2 emissions could be cut even more by the year 2030.
READ MORE ONLINE AT: https://www.click2houston.com/news/ local/2024/02/08/how-green-is-the-powergrid-an-expert-breaks-it-down/
Stores are starting to crack down on out-of-control returns. Barbara Stewart, chair of the Human Development and Consumer Sciences Department, sat down with Fox 26 to share how retailers are limiting returns and best practices shoppers should keep in mind when returning products.
VIEW ONLINE AT: https://www.fox26houston.com/video/1413334
| View Cullen College videos online at youtube.com/UHCullenCollege

BY RASHDA KHAN

BY RASHDA KHAN
Xingpeng Li, is an assistant professor of Electrical and Computer Engineering at the University of Houston, is working on a solution that will allow seamless integration of renewable energy sources with the rest of the power grid without causing any problems.
Li is the one of the latest recipients of the Faculty Early (CAREER) Award from the National Science Foundation for his proposal, “Frequency-Constrained Energy Scheduling for Renewable-Dominated Low-Inertia Power Systems.” The goal of the project is to
ensure that evolving power systems can continue to operate efficiently and stably while supporting fast-growing wind and solar generation.
Li’s research interests include planning and operations of various power energy systems including bulk power grids and microgrids. He leads the Renewable Power Grid (RPG) Lab at UH. He is also the Associate Director of the Power Electronics, Microgrids & Subsea Electrical Systems Center (PEMSEC) at UH.
His lab focuses on energy security, transition, and transmission for both onshore and offshore energy systems. With a goal to promote renewable energy-enriched future power grids, the group proposes new models and algorithms to improve the efficiency and security of energy systems. The lab’s work also contributes to net-zero energy systems by facilitating grid integration of renewables and green hydrogen.

BY STEPHEN GREENWELL
Marzia Cescon, the David C. Zimmerman Assistant Professor of Mechanical Engineering, has received funding for her National Science Foundation (NSF) CAREER proposal, “Data-Enabled Neural Multi-Step Predictive Control (DeMuSPc): a Learning-Based Predictive and Adaptive Control Approach for Complex Nonlinear Systems.”
Cescon described her field of expertise as automatic control –technology that controls processes in order to achieve desired behaviors.
Cescon’s research is concerned with the design of methods and tools to make a system behave in a desired way, while adapting to changing conditions and context, and ensuring safety at the same time. “We achieve that by harnessing data collected with available sensors from the system and its environment to enhance the traditional feedback control loop rooted in model-based design with learning enabled components. We apply the tools that we develop to the automated glucose regulation in people with type 1 diabetes and to the safe and assured autonomous operation of vehicles such as satellites and quadrotors drones.”

BY STEPHEN GREENWELL
Mim Rahimi, is an assistant professor in the Civil and Environmental Engineering Department at the Cullen College of Engineering, has received a National Science Foundation CAREER award for his research proposal into liquid-liquid interfaces for electrochemical carbon capture research.
His research proposal is “Leveraging Liquid-Liquid Interfaces for Innovative Electrochemical Carbon Capture.” It was selected for $537,719 in funding, with research running through August 2029.
“The project aims to advance electrochemical carbon capture (ECC) by employing engineered soft interfaces at liquid-liquid
interfaces between two immiscible electrolyte solutions,” Rahimi said. “This novel approach addresses current ECC process performance limitations, such as the reliance on costly ion-selective membranes and oxygen gas sensitivity. These engineered interfaces will be developed and optimized for enhanced CO2 separation performance and system energetics.”
This is the second significant grant that Rahimi has earned for his research into electrochemical carbon capture in the last two years. In 2023, he received $250,000 in funding from the Department of Energy to create electrochemical tubes to remove dissolved inorganic carbon from synthetic seawater.

BY ALEX KEIMIG
Renita Horton, assistant professor in the Cullen College of Engineering's Biomedical Engineering Department, has received a National Science Foundation (NSF) CAREER Award in the amount of $522,253 for research concerning congenital cardiac fibrosis and vascular cell dysfunction, with support through 2029.
Her proposal ",Congenital Heart on a Chip: Investigating Mechanical, Biomolecular, Cellular and Tissue-Level Mechanisms in Cardiac Fibrosis," aims to investigate "how different cells in the heart respond to chemical and mechanical signals that cause cardiac fibrosis", or the formation of scar tissue within the heart, via two- and three-dimensional chip-based models.
"Chip platforms offer benefits that live models wouldn't necessarily be able to give us," Horton said. "We can do quite a bit more manipulation with a chip model than we can with animals or people, so I see it becoming a more prominent mainstay when it comes to investigating complex disease processes."
The organ-on-a-chip model allows researchers like Horton to isolate cells from whole-organs. This creates a simplified platform to better showcase potential direct effects, which can be challenging with whole organisms. These can include key processes of disease onset, many of which begin before an individual is ever diagnosed and are therefore difficult to study in their entirety.

BY LAURIE FICKMAN

The U.S. Department of Agriculture’s National Institute of Food and Agriculture has chosen a University of Houston project as one of 12 nationwide aimed at improving soil health and productivity through innovative tools and techniques. The UH project will help develop a new nutrient management strategy to grow crops in poor-quality soils and to have higher resistance to climate change.
Healthy soils are like vibrant ecosystems that support plant and animal life, improve water and air quality, and boost the overall
soil and plant systems, has lofty goals: It may not only solve several agricultural productivity issues, but may also do no less than improve carbon capture and storage, which can be an ideal strategy to overcome the impacts of climate change.
THE EFFORT COMES NOT A MOMENT TOO SOON
A combination of factors — including changes in rainfall patterns, increased incidences of drought and unprecedented heatwaves - have all led to soil salinization, a condition where salt builds up in the soil, making it harder for plants to grow.


Over time, this salt can accumulate in the soil, which can harm plants by making it difficult for them to take in water and nutrients.
In the end, the crop’s growth and food production will be affected, which can be especially detrimental for crops that provide both income and essential nutrients.
Silicon is a quasi-essential soil element widely distributed in the earth’s crust and accessible to plants as silicic acid, which can improve plant growth, photosynthesis and resistance to drought and heat. Very little is known about how silicon can influence carbon storage and capture in saline agricultural soils.
“This project will help us learn how silicon affects the way carbon is stored in the soil around plant roots, called the rhizo-
sphere, when there’s too much salt,” said Khan. “We’ll also find out how silicon moves into the parts of soybean plants that grow above the ground.”
Khan will also examine how silicon affects soybean plants when they're under stress from too much salt in the rhizosphere, exploring how the plants’ bodies and their internal processes at the molecular level change in response to silicon.
The project research will help develop a new nutrient management strategy to grow crops in poor-quality soils and increase their resistance to climate change.
Co-investigators of the project from the University of Houston are Venkatesh Balan and Shuhab Khan from the Department of Earth and Atmospheric Sciences. Also on the team are Ram Ray, Prairie View A&M University and Ayalew Osena, UNC Greensboro.


BY LAURIE FICKMAN
With a multi-million-dollar grant from NASA, the University of Houston will open an aerospace engineering research center to support the space agency's strategic goal of extending human presence on the moon and Mars for sustainable, long-term space exploration, development and utilization.
The center will be called NASA MIRO Inflatable Deployable Environments and Adaptive Space Systems (IDEAS2) Center at UH. The $4,996,136 grant is funded by the NASA Office of STEM Engagement Minority University Research and Education Project (MUREP) Institutional Research Opportunity (MIRO) program. MUREP also supports another of NASA’s goals - to develop a talented and diverse aerospace workforce and build the next generation of space explorers. NASA is awarding approximately $45 million to 21 higher education institutions to help build capacity for research.
“The vision of the IDEAS2 Center is to become a premier national innovation hub that propels NASA-centric, state-of-the-art research and promotes 21st-century aerospace education,” said Karolos Grigoriadis, Moores Professor of Mechanical Engineering and director of the Aerospace Engineering Graduate Program at UH, who spearheaded the effort and will lead the center.
Researchers at the IDEAS2 Center will work closely with the Johnson Space Center to contrib-

Our mission is to establish a sustainable nexus of excellence in aerospace engineering research and education supported by targeted multi-institutional collaborations, strategic partnerships and diverse educational initiatives.
- KAROLOS GRIGORIADIS

Karolos Grigoriadis
ute to the robust, scalable orbital and surface infrastructure and operational autonomy that will enable humans to live and work in space, establish a lasting presence on and around the moon, and pave the way toward Mars exploration.
“Our mission is to establish a sustainable nexus of excellence in aerospace engineering research and education supported by targeted multi-institutional collaborations, strategic partnerships and diverse educational initiatives,” Grigoriadis said.
The center will collaborate with Texas A&M University, Stanford University, Houston Community College, San Jacinto College and industrial partners Boeing, Axiom Space, Bastion Technologies and Lockheed Martin.
“The center’s research-integrated educational activities will encompass graduate, undergraduate and middle/high school students, providing opportunities for research, experiential learning and STEM engagement in aerospace to excite their imagination, enrich their education and promote their pathway to aerospace careers,” Grigoriadis said.
BY BRYAN LUHN

A new, $3 million gift will help reinforce the University of Houston’s long-standing mission to provide students with a world-class education and ensure they are given every opportunity to succeed in and out of the classroom.
The Houston Works Scholarship Fund will provide scholarship support to working junior and senior students in all majors at the Cullen College of Engineering and select majors in the Technology Division.
“It is no secret that the University of Houston is home to hard working students, and that goes double for those Cougars holding down full-time jobs while taking classes,” said Diane Chase, senior vice president for academic affairs and provost at UH. “This generous gift will provide support for many of our Coogs balancing school with professional obligations. Beyond its impact at UH, it will bolster our region by helping future leaders focus on their studies and prepare to make an impact within their respective communities.”
The generous gift is a significant step in the University’s larger effort to raise $300 million for scholarships.
“Scholarships are more than financial support; they are a testament to the belief in our students' potential,” said Eloise Brice, vice president for advancement and alumni at UH. “By supporting working students, this generous gift reaffirms our commitment to their success and creates a legacy that honors the University’s core values of hard work and commitment."
Funded by an anonymous donor, the scholarship award for full-time students who work at least 20 hours per week will be $4,000 per academic semester, or a maximum annual award of $8,000.
"Thanks to this gift, our students are not just learning, they are innovating, leading, creating, exploring and discovering,” said Pradeep Sharma, dean of the Cullen College of Engineering. “This gift will allow the College to continue graduating talented students to meet the needs of the industry."
The Houston Works Scholarship Fund:
Aims to empower working students to achieve their academic and career goals. Donations to the fund, which will be matched dollar-for-dollar up to $1 million, will make a lasting impact on the lives of students and contribute to the development of a skilled and educated workforce, further strengthening our community and society.
Four staffers at the Cullen College of Engineering have been recognized and awarded for their exemplary work as employees by the University of Houston.
JAE-HYUN RYOU

Associate Professor Mechanical and Aeropsace Engineering

Assistant Professor William A. Brookshire Department of Chemical & Biomolecular Engineering

Assistant Professor Construction Management

Assistant Professor Human Development and Consumer Sciences

BY STEPHEN GREENWELL
A celebratory contingent of cougars took over city hall on the afternoon of Tuesday, June 4, 2024, as the Houston City Council issued a proclamation for Cullen College Day.
The proclamation was sponsored by Sallie Alcorn, At-Large position 5, and Fred Flickinger, District D councilman.
“The City of Houston is globally known as one of the world's leading engineering and technology cities, and it is also recognized as a place where global business thrives,” Alcorn said, reading from the proclamation. “The Cullen College of Engineering at the University of Houston is a premier institution of higher education that aims to transform lives, organization and society, founded on research and offering a state-of-the-art student-centered education that is accessible and affordable.”
Whitmore acknowledged Alcorn's excitement for the proclamation and added in, joking, “UH sure gets you excited! But once again, you're showing how important UH is to our community.”
Zafar “Zaf” Tahir, a successful businessman and lawyer that earned his B.S. in electrical engineering from Cullen in 1984, thanked the council for the honor. He noted that he was grateful for the opportunities that he had been provided by the city and by the university.
“I think I'm the luckiest Houstonian,” he said. “I'm an immigrant who went to the University of Houston college of business, college of engineering. This town really make you part of it. I wouldn't be anywhere else.
He was followed by Pradeep Sharma, Dean of the Cullen College of Engineering and Hugh Roy and Lillie Cranz Cullen
Distinguished University Professor. He also expressed his gratitude toward the council for the honor.
“Our talented engineers come from many diverse backgrounds,” he said. “We are local, but we offer world class education with global passions.”
He added that with the city's support, the College could build on its areas of strength in both engineering and technology.
“I'm confident with your support, the Cullen brand will be associated as the same quality brand as the City of Houston,” he said.

BY STEPHEN GREENWELL
The University of Houston's Cullen College of Engineering is now ranked at 68th overall in the latest yearly rankings by the U.S. News & World Report of Best Engineering Schools.
“I'm thrilled that the College has improved in the latest U.S. News and World Report rankings, but our journey upwards will continue unabated,” said Pradeep Sharma, Dean of the UH Cullen College and Hugh Roy and Lillie Cranz Cullen Distinguished University Professor. "Our vision is to make us a destination college for engineering and technology in the state of Texas and beyond.”
The University of Houston's Cullen College of Engineering is now ranked at 68th overall in the latest yearly rankings by the U.S. News & World Report of Best Engineering Schools.
“I'm thrilled that the College has improved in the latest U.S. News and World Report rankings, but our journey upwards will continue unabated,” said Pradeep Sharma, Dean of the UH Cullen College and Hugh Roy and Lillie Cranz Cullen Distinguished University Professor. "Our vision is to make us a destination college for engineering and technology in the state of Texas and beyond.”
The Industrial Engineering program had the biggest jump for individual departments, moving up six spots to 44th overall. Petroleum Engineering remains in the Top 10 nationally, improving two spots to seventh overall. Chemical Engineering improved four places, to No. 30, and Electrical Engineering moved up three spots, to No. 82. Mechanical Engineering moved up one slot, to No. 70.
• Biomedical Engineering — No. 90
• Chemical Engineering — No. 30
• Civil Engineering — No. 69
• Electrical Engineering — No. 82


• Environmental Engineering — No. 71
• Industrial Engineering — No. 44
• Materials Engineering — No. 91
• Mechanical Engineering — No. 70
• Petroleum Engineering — No. 7

Pradeep Sharma Wins
Cozzarelli Prize For Paper On Musical Perception
BY LAURIE FICKMAN


When Pradeep Sharma, Hugh Roy and Lillie Cranz
Cullen Distinguished University Professor of Mechanical Engineering and dean of the Cullen College of Engineering, won the Proceedings of the National Academy of Sciences (PNAS) 2023 Cozzarelli Prize, it was music to his ears on different octaves. First, his paper is the only winner in the Engineering and Applied Sciences category chosen from more than 3000 research articles that appeared last year in PNAS. Another key for Sharma’s concerto of cheer is because the paper examines the complex phenomenon of musical perception and begins to answer the incredibly complex question, ‘Why do some people hear music better than others?’
There is no treble in seeing the full expression of originality in Sharma’s article, “A minimal physics-based model for musical perception,” in which he examines why some people, entirely untrained in music, can listen to a song
Variation
in the physical properties of the auditory system, such as the hair cells of the internal ear, may partially account for differences in people’s ability to perceive musical tones,
- PRADEEP SHARMA
and replicate it on a piano with unnerving accuracy. What enables some to “hear” music so much better than others?
“Variation in the physical properties of the auditory system, such as the hair cells of the internal ear, may partially account for differences in people’s ability to perceive musical tones,” reports Sharma in the article.
Sharma and team developed a physics-based model of the mechanics of the hair cells of the inner ear to understand how it perceives multiple tones and its ability to clearly distinguish between two pitches.
“The physics-based model explains how the geometry and electromechanical properties of hair cells may influence musical perception. The model also explores the impact of factors external to the auditory system, including medications such as ibuprofen,” Sharma notes.

BY RASHDA KHAN
In the quest for more efficient and sustainable energy solutions, a multi-university research team has reached a significant milestone in capacitor technology. Researchers from the University of Houston, Jackson State University and Howard University have developed a new type of flexible high-energy-density capacitor, which is a device that stores energy. Though the prototype device is just 1-inch by 1-inch, scaled-up versions of this groundbreaking innovation could potentially revolutionize energy storage systems across various industries, including medical, aviation, auto (EV), consumer electronics and defense.
“High-energy and high-power capacitors are essential for a reliable power supply, especial-
ly as we shift to using more renewable energy sources. However, current dielectric capacitors don't store as much energy as other types of energy storage devices such as batteries. The higher power density of capacitors makes them more attractive for a multitude of applications as compared to batteries,” said Alamgir Karim, Dow Chair and Welch Foundation Professor of Chemical Engineering at the Cullen College of Engineering. He was the faculty mentor on the team.
In this study, the researchers designed a new type of capacitor using layered polymers with oriented 2D nanofillers. They used mechanically exfoliated flakes of 2D materials as nanofillers. The researchers maximized
energy storage by arranging these materials in specific layers, creating a sandwich-like structure to improve capacitor performance. The resulting sandwich is ultra-thin, thinner than human hair. This new design showed improved performance with higher energy density and efficiency than capacitors with randomly blended-in nanofillers.
"Our work demonstrates the development of high energy and high-power density capacitors by blocking electrical breakdown pathways in polymeric materials using the oriented 2D nanofillers," said Maninderjeet Singh, who earned a Ph.D. in chemical engineering at UH last year and is the first author on the paper along with Priyanka Das from

Jackson State University. "We achieved an ultra-high energy density of approximately 75 J/cm³, the highest reported for a polymeric dielectric capacitor to date."
The research team utilized materials like mica and hexagonal boron nitride (hBN) to demonstrate the effectiveness of controlling 2D nanosheet orientation in blocking electrical breakdown pathways. Surprisingly, significant enhancements in dielectric permittivity were observed even with a minimal volume fraction (1%) of nanofillers.
Given that the researchers demonstrated the first-of-its-kind use of stratified multilayered nanocomposites for the design of polymeric
energy storage devices, Karim and Professor Dharmaraj Raghavan from Howard University, a nanocomposite expert expect these hybrid capacitors to be used in a broad range of applications in the future and plan to keep working to extend the energy storage capabilities by developing continuous organic-inorganic interfaces in such nanocomposites.
In addition to this breakthrough, the team has been researching other polymeric systems including polymer topology manipulation, polymer grafted nanoparticles, layered block copolymers in their quest for developing high energy density capacitors for a clean future.


BY BRYAN LUHN

Three Cullen College projects are among those that the U.S. Department of Energy (DOE) recently announced $17.4 million in funding in 19 early-stage research projects focused on expanding clean energy technologies. These projects will establish:
A Comprehensive Roadmap for Repurposing Offshore Infrastructure for Clean Energy Projects in the Gulf of Mexico — The Gulf of Mexico is home to more than 1,500 platforms, 14,000 wells and 10,000 miles of pipelines. Once these assets reach the end of their fossil energy use, they are decommissioned – usually meaning plugged and abandoned wells, as well as pipeline and equipment that are taken apart and brought back to shore or sunk to the ocean floor. University of Houston researchers plan to explore ways to prolong the life of such assets by repurposing them for clean energy projects like wind power, hydrogen generation, and carbon sequestration. The study will create a detailed plan covering technical, social, and regulatory aspects, as well as available resources. It will also identify community resources, government incentives, legal requirements, and industry concerns. The aim is to help communities, investors, and industry to engage in such projects.
The project, which received $749,992, is led by Ram Seetharam, UH Energy program officer. Harish Krishnamoorthy, associate professor of electrical and computer engineering, is the principal investigator. Distinguished Professor of Engineering Kaushik Rajashekara and Gail Buttorff, instructional assistant professor with the Hobby School of Public Affairs, serve as co-PIs.
HOUSTON HYDROGEN TRANSPORTATION PILOT — The current push for widespread use of battery electric vehicles overlooks consumers without access to overnight or workplace charging. While California has hydrogen supply for fuel cell electric vehicles, adoption is low due to limited hydrogen supply and its high cost compared to gasoline or diesel. This project addresses both issues. University of Houston researchers, in collaboration with a Prairie View A&M University colleague, plan to demonstrate potential for a hydrogen refueling pilot in Houston to show how existing infrastructure in the greater Houston area can be repurposed for zero-emission transportation fueled by profitable, low-carbon hydrogen. The first phase of the project will focus on creating a system to optimize hydrogen supply and demand options for the pilot, analyzing environmental and community risks. The second phase will establish a workforce training network to develop skills to support hydrogen fuel supply.
The project, which received $750,000 in DOE funding, is led by Christine Ehlig-Economides, Hugh Roy and Lillie Cranz Cullen Distinguished University Chair of Petroleum Engineering, and managed by Joe Powell, founding executive director of the UH Energy Transition Institute. Co-PIs are Stanko Brankovic, professor of electrical and computer engineering at UH and Honeywell Endowed Professor Raghava Kommalapati at PVAMU.
Synergizing Minority-Serving Institution Partnerships for Carbon-Negative Geologic Hydrogen Production — For this multi-institutional project, Stanford Doerr School of Sustainability is establishing a visiting scholars program that will bring students from Texas Tech University and UH to the Stanford campus to focus on on creating carbon-negative hydrogen from rocks beneath the Earth's surface. The goal is to train the next generation of engineers and scientists from UH and Texas Tech, two Hispanic-serving institutions, to advance early-stage carbon-negative hydrogen production. Visiting scholars from UH and TTU will spend one month per year for three years at Stanford, conducting on-site research and publishing findings. The research focus will include studying rock properties, reactions during carbon dioxide carbonation and hydrogen generation, optimizing performance, and assessing economic and environmental impacts.
Tapan Mukerji with the Stanford Doerr School of Sustainability is the principal investigator on this project, which received $1.5 million in DOE funding. Kyung Jae Lee, associate professor in the Department of Petroleum Engineering at UH is on the team along with Qingwang (Kevin) Yuan, assistant professor of petroleum engineering at TTU and Anthony Kovscek, professor of energy science and engineering at Stanford.
“These three projects show the relevance and quality of the research at UH and our commitment to making a meaningful impact by addressing society’s needs and challenges by doing critical work that impacts the real world,” said Ramanan Krishnamoorti, vice president for energy and innovation at UH. “The success of these project could attract investment, create jobs, produce clean energy, save costs, reduce carbon emissions, and benefit not only the greater Houston area, but the Gulf Coast and beyond.”
Projects were chosen through the DOE Office of Fossil Energy and Carbon Management’s (FECM) University Training and Research program, which aims to create research and development opportunities for traditionally underrepresented communities as well as educate and train future engineers and scientists dedicated to advancing integrated solutions key to achieving a net-zero emissions economy by 2050. “Obtaining this DOE funding not only showcases the caliber and strength of our research, but it also reaffirms the pivotal role UH Energy plays in leading the energy transition,” said UH President Renu Khator. “The work we are doing at UH is driving the urgent shift toward a cleaner and more efficient energy future and benefiting our communities."
BY LAURIE FICKMAN
On the morning of June 6, 2023, a substantial portion of the Kakhovka Dam in Ukraine — vital for water management and hydroelectric power generation — suffered a collapse while under Russian control. Russia had seized the dam early into its invasion of Ukraine, and though independent investigations suggested that Russia destroyed it to prevent a counterattack from Ukraine, Russia has denied responsibility.
New findings published in the journal Nature Communications Earth and Environment, from a University of Houston spaceborne-monitoring team, indicate the dam may have had deformation hotspots before the war, pre-dating the actual collapse.
“Through our analysis, we observed displacements characterizing different segments of the dam, up to two years prior to the actual collapse,” reports UH assistant professor of Civil and Environmental Engineering Pietro Milillo
In the article, Milillo and team present the results of a methodology called InSAR (Interferometric Synthetic Aperture Radar) which measures infrastructure deformation from space with millimetric accuracy using radar images of the Earth's surface collected from orbiting satellites.
The findings came about while the team was conducting a study monitoring the stability of infrastructure during the Russian invasion of Ukraine. By leveraging spaceborne technology, the team, including the German Aerospace Center (DLR) and the Delft University of Technology (TU Delft) uncovered previously unseen details of the pre-collapse of the dam and detected movements and deformations in the
dam years before the collapse, providing valuable insights into its stability.
"This study highlights the significance of proactive monitoring and the role of remote sensing in ensuring the safety and integrity of critical infrastructure,” said lead author Amin Tavakkoliestahbanati, co-author and graduate student in Geosensing System Engineering in the Civil and Environmental Engineering Department at UH. "Our findings emphasize the importance of continuous surveillance to detect and address potential risks before they escalate into catastrophic events."
“Only in recent times are we able to observe such phenomena thanks to the increased number of satellites flying in space capable of such measurements,” said Milillo, who is also a visiting scientist at DLR.
“Current hypotheses ascribe the collapse of the dam to an explosion that occurred on June 6, 2023. Although our analysis cannot exclude an explosion that occurred on that date, they can identify existing damage mechanisms that might have affected the dam before its collapse,” said Milillo.

Milillo said that the data in the study support the hypothesis that the structure was moving downward since June 2021. “With the beginning of the war, neglected dam maintenance and operations might have destabilized the structure over specific areas, favoring the development of the above-mentioned mechanisms,” he said.
The research not only offers valuable insights into the events leading to the collapse of the Kakhovka Dam but also underscores the potential of InSAR as a proactive monitoring tool for infrastructure stability assessment.
As the world faces increasing challenges related to climate change and geopolitical instability, such studies pave the way for more informed decision-making processes and enhanced risk assessment strategies. InSAR’s ability to detect and quantify ground movements with high precision and over extended periods of time contributes to enhanced risk assessment, forensic engineering activities and informed decision-making processes.

The research was supported by the NASA Decadal Survey Incubation Studies. Joining Tavakkoliestahbanati and Milillo on the project were Giorgia Giardina and Hao Kuai at TU Delft.

BY ROBERTO BALLARINI AND LARRY YI-LUNG MO
On September 21, 1999, the 7.3 magnitude “Chi-Chi earthquake” struck Taiwan, killing more than 2,400 people. Chi-Chi, subsequently referred to as the “Jiji earthquake,” was the second-deadliest earthquake in Taiwan's recorded history, after the 1935 Shinchiku-Taichū earthquake. The earthquake caused the collapse of 51,000 buildings and partially destroyed as many as that.
On April 3, 2024 — about 25 years later — Taiwan experienced the 7.2 magnitude “0403” earthquake, but remarkably the death toll was limited to a reported 14 people, none of which died as a result of a building collapse. In fact, 0403 significantly damaged only a handful of buildings.
The extraordinary difference between the destruction in 1999 and 2024 is, in large part, the result of the research conducted at Taiwan’s National Center for Research on Earthquake Engineering (NCREE), a global leader in earthquake engineering research. Such research is a national priority because Taiwan is located near the junction of two tectonic plates.
For the past 25 years, the Department of Civil and Environmental Engineering at the University of Houston's Cullen College of Engineering has had a fruitful collaboration with NCREE through the leadership of several professors. This includes Emeritus Moores Professor Thomas Hsu, who has served as their consultant; Moores Professor Yi-Lung Mo, who served on their advisory board; and Thomas and Laura Hsu Professor Roberto Ballarini, who as Department Chair makes frequent visits

to Taipei to sign the collaborative agreements and to foster continued collaboration between NCREE and UH’s faculty and students.
The research results produced by Hsu and Mo and their graduate students, in collaboration with NCREE researchers, have been adopted into Taiwan's seismic design codes and have been revised as new knowledge became available. Countless buildings, including schools, were retrofitted or restored using the revised seismic design codes.
The synergistic collaboration involves research performed on both the UH Main Campus and at the NCREE laboratories. At UH, the faculty perform comprehensive full-scale testing of structural components
such as beams, columns and thin-walled shells and membranes; they use the experimental results to develop computational models of the components’ responses to dynamic loading; and implement the models into OpenSEES, a Finite Element Method program used across the globe to simulate the response of structures to earthquakes and other dynamic events.
The computational models and associated software developed at UH are validated by the experiments performed at NCREE on large structural systems, including buildings with non-traditional configurations and nuclear containment vessels subjected to cyclic loading and/or shaken on NCREE’s large “shake table.”
The success of the collaboration between UH and NCREE is truly meaningful, as evidenced by the significant differences in casualties and losses between the 1999 and 2024 earthquakes.

BY LAURIE FICKMAN

A University of Houston researcher is reporting a new method to detect cancer which could make cancer detection as simple as taking a blood test. With a 98.7% accuracy rate, the method - which combines PANORAMA imaging with fluorescent imaging - has the potential to detect cancer at the earliest stage and improve treatment efficacy.
The remarkably precise method allows researchers to peer into nanometer-sized membrane sacs, called extracellular vesicles or EVs, that can carry different types of cargos, like proteins, nucleic acids and metabolites, in the bloodstream.
When Wei-Chuan Shih, Cullen College of Engineering professor of electrical and computer engineering, and his team ex-
amined the number and cargo of small EVs inside patients with cancer and those without, their finding was remarkable.
“We observed differences in small EV numbers and cargo in samples taken from healthy people versus people with cancer and are able to differentiate these two populations based on our analysis of the small EVs,” reports Shih, in Nature Communications Medicine. “The findings came from combining two imaging methods – our previously developed method

tional Institutes of Health, it was a matter of counting the number of small EVs to detect cancer.
“Using a cutoff of 70 normalized small EV counts, all cancer samples from 205 patients were above this threshold except for one sample, and for healthy samples, from 106 healthy individuals, all but three were above this cutoff, giving a cancer detection sensitivity of 99.5% and specificity of 97.3%,” said Shih.
To further test the performance of the detection threshold of 70 normalized small EV counts in plasma, the team analyzed two independent sets of samples from stage I-IV or recurrent leiomyosarcoma/ gastrointestinal stromal tumors and earlyand-late-stage cholangiocarcinoma that were anonymously labeled and mixed in with healthy samples and achieved 100% accuracy.
“With further optimization, our approach may be a useful tool for cancer detection screening in particular and provide insights into the biology of cancer and small EVs,” said Shih.

PANORAMA and imaging of fluorescence emitted by small EVs—to visualize and count small EVs, determine their size and analyze their cargo.”
In 2020, Shih debuted the PANAROMA optical imaging technology, which uses a glass side covered with gold nano discs that allows users to monitor changes in the transmission of light and determine the characteristics of nanoparticles as small as 25 nanometers in diameter. PANORAMA takes its name from Plasmonic Nano-aperture Label-free Imaging (PlAsmonic NanO-apeRture lAbel-free iMAging), signifying the key characteristics of the technology.
For this research, supported by the Na-
His research team includes doctoral students Nareg Ohannesian and Mohammad Sadman Mallick, and collaborators Steven H. Lin, Simona F. Shaitelman, Chad Tang, Eileen H. Shinn, Wayne L. Hofstetter, Alexei Goltsov, Manal M. Hassan, Kelly K. Hunt, from M.D. Anderson Cancer Center. Shih and Lin founded Seek Diagnostics Inc. to commercialize this technology.

BY LAURIE FICKMAN
A team of cancer researchers, led by the University of Houston, has discovered a new subset of T cells that may improve the outcome for patients treated with T-cell therapies.
T cell-based immunotherapy has tremendous value to fight, and often eliminate, cancer. The strategy activates a patient’s immune system and engineers a patient’s own T cells to recognize, attack and kill cancer cells. In this way, the body’s own T cells become living drugs.
While T-cell immunotherapy has revolutionized cancer treatment, there is still much to learn. Unfortunately, not all patients respond to these therapies, so a better understanding of the properties of engineered T cells is necessary to improve clinical responses.
One such study, supported by a grant from the National Institutes of Health, is reported in Nature Cancer by the laboratory of Navin Varadarajan, M.D. Anderson Professor in the William A. Brookshire De-
partment of Chemical and Biomolecular Engineering. The study uses the patented TIMING (Timelapse Imaging Microscopy in Nanowell Grids) approach which applies visual AI to evaluate cell behavior, movement and ability to kill.
“Our results showed that a subset of T cells, labeled as CD8-fit T cells, are capable of high motility and serial killing, found uniquely in patients with clinical response,” reports first author and recent UH graduate Ali Rezvan in Nature Cancer.
In addition to the UH team, collaborators include Sattva Neelapu and Harjeet Singh, The University of Texas MD Anderson Cancer Center, Houston; Mike Mattie, Kite Pharma; Nabil Ahmed, Texas Children’s Hospital, Baylor College of Medicine, Houston; and Mohsen Fathi, CellChorus.
To discover the CD8-fit cells, the team used TIMING to track interactions between individual T cells and tumor cells across thousands of cells and integrated the results with single-cell RNA sequencing data.
“Chimeric antigen receptors (CAR) T cells used for the treatment of B cell malignancies can identify T-cell subsets with superior clinical activity. Using infusion products of patients with large B cell lymphoma, we integrated functional profiling using TIMING with subcellular profiling and scRNAseq to identify a signature of multifunctional CD8 T cells (CD8-fit),” said Rezvan. “We profiled these cells using single-cell RNA sequencing to identify the CD8-fit molecular signature that could be used to predict durable patient outcomes to T-cell
The strategy activates a patient’s immune system and engneers a patient’s own T cells to recognize, attack and kill cancer cells.
therapies and validated our findings with independent datasets.”
The team also found that the CD8-fit signature is present in pre-manufactured T cells, longitudinally persists in patients post-infusion, and most importantly, is associated with long-term positive clinical responses. According to the researchers, it is likely that these T cells can drive clinical benefit in other tumors.
“This work illustrates the excellence of graduate students Ali Rezvan and Melisa Montalvo; and post-doctoral researchers Melisa Martinez-Paniagua and Irfan Bandey among others,” said Varadarajan.
CellChorus, a spinoff from Varadarajan’s Single Cell Lab at UH, is developing the AI-powered TIMING platform. The company recently announced a $2.5 million Small Business Innovation Research grant from the National Center for Advancing Translational Sciences of the National Institutes of Health to advance TIMING for cell therapy applications.

BY STEPHEN GREENWELL

A researcher at the Cullen College of Engineering has received a renewable grant with a total potential value of about $3.2 million from the National Institutes of Health to expand his research into improving the accuracy of diagnosis for forms of kidney disease.
Rohith Reddy is an assistant professor in the Electrical and Computer Engineering Department, and a Cancer Prevention and Research Institute of Texas (CPRIT) Scholar in Cancer Research. The NIH's National Institute of Diabetes and Digestive and Kidney Diseases chose his proposal, "Improving the Accuracy of Lupus Nephritis Diagnosis using Biomarkers Derived from Ultraviolet and Mid-infrared Spectroscopic Imaging," for funding.

The grant is $629,842 for its first year. If the research shows promise, it is renewable for up to five years, for a total value of about $3.2 million.
Reddy explained that his research's goal is to improve the accuracy of the diagnosis of lupus nephritis, which is a kidney disease where the immune system of the body attacks parts of its own kidney.
"The current problem is that the accuracy of diagnosis is quite poor," he said, noting that in some cases, diagnosis accuracy is as low as 50 percent.
"To improve the diagnosis, we need a more objective stan-
dard and methods. We are introducing two new technologies and combining information intelligently. One technology is based on ultraviolet light, and the other on infrared light, utilizing both shortwave and long wavelengths. By integrating information from both, we aim to enhance the diagnostic process."
According to Reddy, the idea for the research came out of prior work to improve the accuracy of gynecologic ovarian cancer diagnoses. He also noted that his proposal was refined thanks to collaboration with his Cullen peers David Mayerich — an associate professor in the Electrical and Computer Engineering Department, and another CPRIT Scholar — and Chandra Mohan, Hugh Roy and Lillie Cranz Cullen Endowed Professor of Biomedical Engineering.
Reddy also identified two others with outside affiliations that would be involved in the project — Kyung Hyun Lee, an assistant professor of Biostatistics at UT Health's Center for Clinical Research and Evidence-Based Medicine; and Anthony Chang, a Professor of Pathology at the University of Chicago.
He added that his past and future research wouldn't be possible without the hard work of the students he oversees.
"As an assistant professor, like any professor at any level, you rely on your students and postdocs to do a lot of the work because one person can only do so much," he said. "They are the ones performing many of the experiments and handling hands-on tasks. I'm very thankful to have good students."
Reddy said he was "ecstatic" to receive the NIH funding. He noted that it wouldn't have been possible without the earlier $2 million in funding he received from CPRIT to establish his laboratory when he first joined Cullen as a postdoctoral researcher from Harvard Medical School. There, he worked directly on patient-centric devices, which had a strong influence on his research goals.
"I have always been fascinated by biomedical engineering, and my Ph.D. was in bioengineering," he said. "Although I'm an engineer, I have a deep interest in the medical field. This interest motivated me to pursue my postdoctoral fellowship at Harvard Medical School. I worked on devices that were used immediately in a hospital setting at Massachusetts General Hospital."
"We made imaging devices and took them to the hospital for direct patient studies. That kind of work keeps me motivated because I know our efforts will impact human happiness and patient health. It may not be instantaneous because it's research and will take some time to reach the hospital. However, I'm confident that the research we're doing will ultimately save lives in the future, and that is what truly keeps me motivated."

They are the ones performing many of the experiments and handling hands-on tasks. I'm very thankful to have good students

- ROHITH REDDY
BY STEPHEN GREENWELL
A professor from the William A. Brookshire Chemical and Biomolecular Engineering Department at the Cullen College of Engineering is part of a collaboration between researchers at three universities to redesign robotic hands to increase their dexterity.
Alamgir Karim, the Dow Chair and Welch Foundation Professor, as well as the director of the International Polymer & Soft Matter Center (IPSMC) and the director of the Materials Engineering Program, is a co-PI for the proposed research, “Bio-Inspired Design of Robot Hands for Use-Driven Dexterity.”
According to the project's abstract, its goal is to “create a transformative, bio-in-

spired re-design of the robotic hand. A new approach to robot hand design can bring results with national impact.” An estimated 400,000 Americans are living with some form of upper limb loss, and the researchers aim to redesign the robot hand for greater functional dexterity.
The total grant amount is $650,000. The principal investigator is Nancy Pollard, a
professor in the Robotics Institute and the Computer Science Department at Carnegie Mellon University. An additional co-PI is Joohyung Kim, an associate professor in the Electrical & Computer Engineering Department at the University of Illinois Urbana-Champaign's Grainger College of Engineering.
The research is estimated to run through December 2024. Funding is provided via the NSF's Convergence Accelerator Track M, which addresses national-scale societal challenges through use-inspired convergence research. About $10 million in funding was provided for 15 different projects by the NSF in February.

A new approach to robot hand design can bring results with national impact.
- ALAMGIR KARIM
BY LAURIE FICKMAN
New biomarkers with improved diagnostic performance for early detection of lupus nephritis have been discovered in the University of Houston lab of Chandra Mohan, a pioneer in lupus research. Early identification of renal involvement in lupus and prompt treatment are essential in reducing the pain, suffering and eventual mortality it causes.
Systemic Lupus Erythematosus (SLE), commonly called lupus, is an autoimmune disease that occurs when the body attacks its own tissues and organs. Inflammation from the disease can impact many different parts of the body including joints, skin, kidneys, blood cells, brain and heart. Lupus nephritis is one of the most frequent and severe clinical manifestations of SLE, and the leading cause of death.
As reported by Mohan, Hugh Roy and Lillie Cranz Cullen Endowed Professor of Biomedical Engineering, in the Journal of Autoimmunity, “These studies add at least six novel urine biomarkers of active renal lupus validated across two ethnically diverse patient cohorts.”
“We and others have reported several urine proteins that can serve as harbingers of renal involvement in lupus. Here, we report on a novel technique based on the
use of antibodies and DNA amplification that can detect even low concentrations of proteins. This technique is called Proximity Extension Assay (PEA),” said Mohan.
By applying PEA proteomics (the study of protein interactions, function, composition and structures) to urine samples, Mohan and team identified several proteins that were significantly elevated in the urine of lupus patients with active renal disease.
The study offered independent validation of several previously reported urine biomarkers for active renal lupus, including proteins such as ALCAM, CD163, MCP1, SELL, ICAM1, VCAM1, NGAL and TWEAK. The researchers also identified additional urine protein biomarkers not previously reported, including ICAM-2, FABP4, FASLG, IGFBP-2, SELE, and TNFSF13B/BAFF.
Examining the renal expression of these molecules suggests that both immune cells and non-immune cells in the kidneys may be releasing these biomarker proteins into the urine.
"These studies have expanded the repertoire of urinary proteins that can be used to monitor renal status in a patient with lupus,” said Mohan, whose team includes lead author, post-doctoral fellow, Yaxi Li; Dr. Ramesh Saxena, UT Southwestern, Dallas; Dr. Chi Chiu Mok, Tuen Mun Hospital, Hong Kong; and Claudia Pedroza and Kyung Hyun Lee, UTHealth Houston.

BY LAURIE FICKMAN






It makes less-expensive, higher-quality studies accessible to a broader community, enabling improved sleep research and more personalized, accessible sleep-related healthcare interventions.
-BHAVIN R. SHETH

Bhavin R. Sheth, an associate professor of electrical and computer engineering, and former student Adam Jones have introduced a groundbreaking approach to sleep stage classification that could replace the current gold standard in sleep testing, the cumbersome polysomnography, which uses a myriad of wires and is performed in a clinic. Their new procedure, which can be performed at home by the user, uses a single-lead electrocardiography-based deep learning neural network.
If you’ve ever had a problem sleeping, and ended up in a sleep lab, you know the polysomnography test is anything but restful. With a multitude of leads — sensors and wires — dangling from every part of your body, you are asked to sleep, which is a state difficult to reach without such encumbrance, nearly impossible with it.
But what if the number of those electrodes - attached from your scalp to your heart – was reduced to simply two?
“We have successfully demonstrated that our method achieves expert-level agreement with the gold-standard polysomnography without the need for expensive and cumbersome equipment and a clinician to score the test,” reports Sheth in Computers in Biology and Medicine. “This advancement challenges the traditional reliance on electroencephalography (or EEG) for reliable sleep staging and paves the way for more accessible, cost-effective sleep studies.”

Even more, by enabling access to high-quality sleep analysis outside clinical settings, Adam and Bhavin’s research holds the potential to expand the reach of sleep medicine significantly.
Reliable classification of sleep stages is crucial in sleep medicine and neuroscience research for providing valuable insights, diagnoses and understanding of brain states. Although commercial devices like the Apple Watch, Fitbit and Oura Ring track sleep, their performance is well below that of polysomnography.
The electrocardiography-based model was trained on 4000 recordings from subjects 5–90 years old. They showed that the model is robust and performs just as well as a clinician scoring polysomnography.
“Our method significantly outperforms current research and commercial devices that do not use EEG and achieves gold-standard levels of agreement using only a single lead of electrocardiography data,” said Sheth, who is also a member of the UH Center for NeuroEngineering and Cognitive Systems.'
“It makes less-expensive, higher-quality studies accessible to a broader community, enabling improved sleep research and more personalized, accessible sleep-related healthcare interventions.”

BY LAURIE FICKMAN
The University of Houston is collaborating with Texas A&M University to tackle the challenge hindering the use of Additive Manufacturing (AM), commonly known as 3D printing, for a variety of commercial applications – the need for real-time monitoring and analysis to ensure consistent quality and reproducibility throughout the production process.
At present, quality control and qualification of metal AM parts is mostly carried out through offline inspection and characterization, but ideally, a broad range of sub-surface and bulk microstructural features should be evaluated in real-time, at the speed of fabrication in an AM tool.
“The objective of our project is to accomplish this goal by the development of real-time, comprehensive, in-situ sub-surface and bulk structural analysis of AM parts during fabrication, and integration with multi-modal data from various in-situ sensors, that can bridge the critical knowledge gap between process


conditions and properties,” said Venkat Selvamanickam, M.D. Anderson Professor of Mechanical Engineering at UH, who is leading the project through the UH Advanced Manufacturing Institute (AMI), which he created. The project is supported by a $957,849 grant from NIST The National Institute of Standards and Technology.
Preliminary study has confirmed that sample-to-sample differences due to varying AM process conditions are identifiable via two-dimensional X-ray diffraction (2D-XRD).
“We will design, construct and install a custom in-line 2D-XRD in the hybrid Directed Energy Deposition tool in AMI facilities at University of Houston. This tool offers a robust platform that includes features such as multi-material deposition (for spot-alloying and functional grading) and several in-situ sensors for process monitoring,” Selvamanickam said.
Since its formation in 2018, AMI, a University-wide center, serves as a pivotal hub for advancing the scale-up and commercialization of technologies developed by UH faculty, facilitating the transition from idea to manufac-
turing and eventual market deployment. The project on additive manufacturing follows a successful track record of AMI in scaling up superconductor manufacturing technologies for industrial applications.
Ying Lin, associate professor of industrial engineering and Goran Majkic, research professor of mechanical engineering at UH join Selvamanickam on the research team. At Texas A&M University, Ali Erdemir, professor of mechanical engineering and Halliburton Chair, will coordinate the program and the Texas A&M team includes Mathew Kuttolamadom, associate professor of engineering technology and industrial distribution.
To be sure, AM is revolutionizing the way metal structures are fabricated for many applications in aerospace, automotive, energy, medical and other industries. But widespread use of is contingent on meeting the stringent requirements of quality and repeatability of parts made by this process.
“Such an achievement will tremendously expand the use of metal additive manufacturing in many applications,” Selvamanickam said.
BY LAURIE FICKMAN
Incorporation of Molecules Occurs in Two Steps, Divided by an Intermediate State
A million years ago, the oldest known species to walk upright like a human, the Homo erectus, had a human-like fascination with crystals. Historians can even pin down the possible reasons – crystals didn’t look like anything around at the time - trees, valleys, mountains. Crystals were a material to ponder, a fascinating diversion for the mind.
To this day, the human preoccupation with the magic of crystals continues to fill the mind’s eye of scientists who have developed ways to use crystals for everything from malaria cures to solar cells and semiconductors, catalysts and optical elements. Over the years crystals have become crucial constituents of the technologies that enable modern civilization.
So, for historians creating a timeline of crystal fascination and research spanning a million years, mark January 2024 as the time that University of Houston researcher Peter Vekilov, Frank Worley Professor of Chemical and Biomolecular Engineering, published in PNAS an answer to how crystals are formed and how molecules become a part of them.
“For decades crystal growth researchers have dreamt of elucidating the chemical reaction between incoming molecules and the unique sites on a crystal surface that accept them, the kinks,” said Vekilov. "The mechanism of that reaction, i.e., the characteristic time scale

and length scale, possible intermediates and their stabilities, has remained elusive and subject to speculation for over 60 years.”
The main obstacle to deeper understanding has been the lack of data on how molecules join in, connected to the complicated process of moving from the solution to where they grow.
To unravel the chemical reaction between a molecule that dissolves in liquid (solute) and a kink, Vekilov mobilized two transformational strategies, one using full organic pairs and the second, using four solvents with distinct structures and functions. Working with the molecules, he combined state-of-the-art experimental techniques including time-resolved in situ atomic-force microscopy at near-molecular resolution, x-ray diffraction, absorption spectroscopy and scanning electron microcopy.
That’s when Vekilov made a revolutionary discovery: Incorporation into kinks may oc-
cur in two steps divided by an intermediate state and the stability of this middle state is key in how crystals grow. It basically decides how fast or slow the crystals form because it affects how easily things can join in during the process.
Though the new discoveries don’t date back to Homo Sapien times, they do solve a 40-year-old riddle for Vekilov.
“The notions of an intermediate state and its decisive role in crystal growth refute and replace the dominant idea in the field, brought up by A.A. Chernov, my PhD advisor, that the activation barrier for growth is determined by the solute-solvent interactions in the solution bulk,” he said.
The new paradigm of two step incorporation, mediated by an intermediate state, could help in understanding how small parts in a liquid can influence the detailed shapes of crystals found in nature.
“Equally important, this paradigm will guide the search for solvents and additives that stabilize the intermediate state to slow down the growth of, for instance, undesired polymorphs,” Vekilov said.

Vekilov’s team includes Jeremy Palmer, Ernest J and Barbara M Henley Associate Professor of chemical and biomolecular engineering; former graduate students Rajshree Chakrabarti and Lakshmanji Verma; and Viktor G. Hadjiev, Texas Center for Superconductivity at UH.










From novel approaches to small-scale farming and off-planet infrastructure to the ever-evolving pursuit of student success, faculty and leadership in the Cullen College of Engineering are "boosting boundaries" as they work together in pursuit of our mission to advance the state of knowledge through pioneering research and scholarly work. These varied disciplines are coming together in meaningfully unique ways to shape the future of innovation in STEM.




BY BRYAN LUHN





Moores Professor of Mechanical Engineering and Mechanical and Aerospace Engineering Department Chair Karolos Grigoriadis has had quite the year.
After nearly three decades as a faculty member of Cullen College's Mechanical Engineering department, he was named as the new Department Chair earlier this year, succeeding Hugh Roy and Lillie Cranz Cullen Distinguished University Professor Pradeep Sharma upon Sharma's own naming as the new dean of the Cullen College.
"I am honored to be named chair and appreciate the support of the department and my colleagues," said Grigoriadis. "It’s certainly a significant change in responsibilities for me. I've been in this department for close to 30 years now, focusing on research and teaching; this new position has a significantly different and expanded role in terms of promoting the department, ensuring that the day-to-day operations are progressing well, and putting in place a vision for expanding the department in terms of its mission."


According to Grigoriadis, the transition of the Mechanical Engineering Department to the Mechanical and Aerospace Engineering Department – another recent and significant change – is "long overdue."
"As 'Space City', Houston is entitled to an aerospace engineering program at its university," he continued. "The new program will respond to the rapidly growing local, regional, and national need for a highly skilled aerospace workforce and advances in aerospace technologies. Currently, our department offers graduate degrees in aerospace engineering and space architecture. We plan to proceed with the introduction of an undergradu ate degree in aerospace engineering and a graduate degree in space engineering. This expansion of our educational and re search programs is a necessary step to ensure we stay in tune with the new space economy and space exploration initiatives."



These initiatives aren't just commercial. In 2017, NASA officially launched the Artemis program, the goals of which include returning humans to the Moon for the first time since 1972 and establishing a permanent base there to facilitate later human missions to Mars. These goals make the industry's needs clear: in order to get to and exist in outer space, we need confident experts at getting to and existing in outer space. Grigoriadis calls this "the workforce that space technology needs for the future": educated and experienced professionals who can produce, operate, repair, and continually improve upon the technology that allows humans to occupy the hostile conditions beyond our atmosphere.
This is just one role of a new NASA-funded research center which opened at UH this fall: The NASA Center for Inflatable Deployable Environmental Adaptive Space Systems, or IDEAS2. With NASA's $5 million grant funding, researchers at the center will conduct cutting-edge research on expandable, modular, and reconfigurable structures needed to develop space infrastructure in lunar orbit and on the surface of the Moon.


At UH, ongoing space research - like this in the space architecture lab of Olga Bannova - allows students to take a virtual spacewalk in a simulated virtual reality environment.








In addition to Texas A&M University, Stanford University, Houston Community College and San Jacinto College, the UH-based center will collaborate with industrial partners Boeing, Axiom Space, Bastion Technologies and Lockheed Martin. A total of fourteen faculty members representing each of the constituent academic institutions will be participating in IDEAS2, with nine of them from the University of Houston.
"I expect that this will be a great collaborative effort, and that working on these technologies will progress the infrastructure needed for these space missions," said Grigoriadis. "The Center's main focus is to innovate the development of infrastructure and technologies that are necessary to support space exploration goals for longterm human presence on the Moon and subsequent missions to Mars. Our vision is to become a premier national innovation hub that propels NASA-centric, state-of-theart research and promotes 21st-century aerospace education."
"This research will support NASA’s space exploration goals and simultaneously provide expanded opportunities to educate students to meet the growing needs of our aerospace engineering workforce," he added.
"The state-of-the-art research and technology that will be developed at this center will build the infrastructure that is needed for our sustainable presence on the moon, and eventually Mars. This will involve deployable, expandable, modular adaptive structures for habitats, communication arrays, solar panels, antennas, large telescopes, heat shields… There is a whole array of infrastructure needs for this purpose. Our objective is to produce innovative architectural design, deployment, assembly adaptation, structural integrity analysis, health monitoring, and other technologies that are needed for these assets."



Karolos Grigoriadis

In addition to investigating and testing invaluable technological work, the IDEAS2 Center will be developing something even more crucial: human capital.
Grigoriadis is confident not only that the undergraduate and graduate students assisting with research at the center will be equipped with the necessary skills to lead Houston and the world into the new space economy, but that their outreach for K-12 students will inspire an entire generation of aerospace engineers and lifelong STEM enthusiasts.
"The educational component of this center will span a broad range of activities, starting with STEM engagement programs for K-12 students. We want to inspire their interest in science, technology and especially space. This is how we will build the workforce that aerospace technology needs for the future," Grigoriadis affirms.
"Innovation is boosting the boundaries – building upon prior knowledge, but pushing that knowledge and progressing technology and research to expand into areas wherein there is a real need to provide new tools, methods, algorithms, and technology. These efforts are consistent not only with our goals in aerospace overall, but for the college's Mechanical and Aerospace Engineering department as well: to respond to this need from the perspectives of technology, research, workforce, education, and innovation."




BY BRYAN LUHN






Three Cullen College researchers are combining their respective talents to support small-scale, underserved and limited-resource farmers with practical solutions to combat the effects of climate warming on global food supply. Their work is part of the University of Houston's contribution to a $5 million cooperative project funded by a grant from the U.S. Department of Agriculture (USDA).
Associate professor of biotechnology Venkatesh Balan, Ph.D. and assistant professor of biotechnology Abdul Latif Khan, Ph.D., are investigating the application of freshwater algae and silica products to improve soil microbiome, stimulate plant growth and improve stress resilience against climatic change. These interventions are expected to reduce dependence on traditional nitrogen-phosphorus-potassium fertilizers. Assistant professor of electrical and computer engineering Xiaonan Shan, Ph.D., is working to design, build, and test low-cost, efficient sensors to record temperature to measure greenhouse gases (GHG), carbon dioxide, and methane levels in agricultural fields. Together, their work forms a unique feedback loop.

"The goal of this project is to educate and encourage low-income and underserved farmers by introducing them to and training them in adopting Climate-Smart practices in the daily operations of their farms," says Shan.
The practices in question are the application of silicon and algae products to agricultural soil and fields, with dual goals of increasing crop health and production and increasing carbon sequestration.








MY LAB IS FOCUSING ON SILICON AS A NUTRIENT MANAGEMENT STRATEGY TO IMPROVE PLANT GROWTH, RESIST CLIMATE CHANGE STRESS, AND REDUCE GREENHOUSE GAS EMISSIONS.
- ABDUL LATIF KHAN



Agriculture contributes approximately 11% of total GHG in the U.S., including carbon dioxide, nitrous oxide, and methane emissions. These emissions are often associated more with livestock than plant crops, but according to Balan, 2.2 metric tons of carbon dioxide are released for every metric ton of traditional fertilizer media produced. On average, roughly 20 million metric tons of nitrogen, phosphate and potash – collectively known as N-P-K - are produced for fertilizer yearly in the United States. That's 44 million metric tons of carbon dioxide.
"The population is increasing drastically, contributing to pollution, and there is a growing demand for food with significant pressure on the agricultural land that provides it," says Balan. "Currently, we're using too much chemical fertilizer to meet demand, but that is increasing GHG emissions and excess fertilizers wash out by rain polluting the waterways, too. There is a certain limit beyond which the soil cannot tolerate any more chemical fertilizers, meaning that over a period of years, no matter how much fertilizer we use, crop yield keeps decreasing because the soil microbiome and soil quality keeps depleting."
So how do climate-conscious farmers proceed? Are there ways to reduce dependence on N-P-K fertilizer, and could the answer be found in nature? How can researchers educate small-scale growers about available interventions and how to apply them? These are exactly the questions the trio intend to help answer. Enter a robotic dog.
Carrying a small array of smart, low-cost sensors, this robotic dog –more formally known as a quadruped robot – can be remotely-controlled to access tough terrain, whether rocky, dry, soft, or grassy, to collect gas samples and other data from a given piece of farmland. The sensors can also be affixed to an airborne drone, which may be limited to clearer terrain but reduces the overall cost for farmers even further. The goal, says Shan, is a wireless network that allows for long-term monitoring of carbon sequestration within soil through the measurement of GHG emissions.
This sequestration is primarily achieved through cultivating healthy, hardy plants – plants that can stand up to increasingly wide ranges of climatic stresses, including rising temperatures and prolonged drought conditions. A photosynthesizing plant is a natural carbon dioxide scrubber, and algae and silicon may be the keys to bolster the health these plants.



"With the passage of time and the effects of our agricultural practices, we are losing microbial diversity from our soil system. That is a key concern for soil scientists and microbiologists alike," says Khan. "My lab is focusing on silicon as a nutrient management strategy to improve plant growth, resist climate change stress, and reduce greenhouse gas emissions."
Silicon's natural ability to maintain moisture in the soil system could also help guard against the stress of drought periods during summer heat. This not only protects the existing crop fields but helps save money and resources on irrigation in an already water-scarce season.
Interventions like this may be attractive to farmers not only because of the study's immediate participation incentives or the potential for increased yield, but because silicon is cheaper than NPK. This means that combining the two may help save on fertilizer costs while simultaneously reducing the demand for carbon-releasing NPK production.
Balan's complementary work focuses primarily on applying microalgae to agricultural fields to reduce GHG emissions.
"The good thing about microalgae is that it does the opposite of what we do with chemical fertilizer production. It consumes 1.8 tons of carbon dioxide for every ton of dry algae reduced," Balan says.
The algae – applied as granules that mix with irrigation water – does its best work when it stays near the plants that need it. A teaspoon of soil contains approximately one billion bacteria; some helpful, some harmful. As a living organism, it is in constant competition for resources.
"Algae are known to produce metabolites to alter its environment to deter toxic organisms and attract good symbiotic organisms. By adding this algal slurry, we can increase the product yield by up to 15% depending on the soil conditions," he adds.
Their research may have significant implications for the future of agriculture, but in keeping the focus on affordable, easy-to-implement interventions, this cooperative study with Prairie View A&M University and Texas A&M University still increases resource equity for small-scale, underserved and limited-resource farmers today.
"It may sound like it's too good to be true," says Balan, "But that's the beauty of nature."







BY ALEX KEIMIG








Dr. Jamison Kovach and students at the Create@UH open house session.
With a background in industrial engineering, research focus on process improvement and organizational problem solving, and black belt certification in innovation engineering, Jamison "Jami" Kovach, PMI Houston Endowed Professor in Project Management and Associate Dean for Student Success and Undergraduate Support Services in the Cullen College of Engineering, sees opportunities for innovation wherever she goes.
"I bring that innovation engineering mindset to this work, too," she says. "I have a very firm definition of innovation that is rooted in my training: innovation is creating things that are meaningfully unique. Something can be new and unique and different, but if it doesn't solve any problems, nobody's going to bite."
It's an efficient way of thinking that guides all areas of her work. Her close collaboration with Senior Associate Dean of Undergraduate Programs and Distance Learning Jagannatha "JR" Rao, whom she considers an invaluable advisor, centers on continually finding new ways to support Cullen undergraduate students throughout their time at the college.






"'Student success' is about supporting our students in achieving their goals: graduating on time, passing their courses, getting the tutoring help and support they need, and feeling like they are part of the community within the Cullen College of Engineering. Graduation rates, passing rates, spirit building - those are a lot of what I'm focused on right now, especially with UH’s goal of becoming one of the top 50 public universities [in the country]."


Kovach cites the implementation of the Pathway Professor role, expanding PROMES (Program for Mastery in Engineering Studies) and other tutoring resources, and Create@UH as "some of [the college's] biggest initiatives" in pursuit of student success.
"When a student chooses Cullen College of Engineering, it becomes our responsibility to help that student be successful," she says.
For example, Pathway Professors "have been specifically identified for their high level of teaching ability and their outstanding performance as instructors" in some of Cullen's most challenging courses and are recognized as the "best of the best".
"We’re also expanding PROMES," Kovach adds. "PROMES Workshops are a great way for students to access peer mentoring and tutoring support on a regular basis. They run in conjunction with classes, and even early on, faculty have shared that those students who participated in PROMES did better in their courses. This Fall, we'll have a big push for more students to enroll in PROMES sections as well as to find more peer tutors to support them."
In addition to college-specific resources, Kovach is collaborating with university-level programs like LAUNCH (Learning Advancements for Undergraduate Cougars of Houston) and the remote peer tutoring program, Knack.
"Whereas PROMES is semester-long and enrollment-based, these other programs are… better suited to discrete or drop-in tutoring needs," Kovach adds. "It's not just about having more resources. Our goal is to be smart about the resources we have within the college and outside of it. Instead of just hiring a ton of tutors, let's see what the University is able to provide, and then let's use our college-level resources to fill in some of the gaps we might find or to supplement those more challenging courses.



"This is also a particular need for our Technology Division programs, because several of them are located fully at the Sugar Land instructional site. We need to make sure that students there feel supported in the same manner as our students on the central campus."
Some specialized college-level resources, however, just can't be beat; that's the case with Kovach's newly established Create@UH program in support of curricular-based design activities for all undergraduate engineering majors.
Create@UH is all about increasing and enhancing design resources: opening more multidisciplinary labs and makerspaces for students to work on curricular-based design projects, working to bring in more funding and industry support for these student design projects, and proudly showcasing their work. Kovach describes it as "one of the biggest initiatives" her office has undertaken recently.
For example, Capstone Design is a "culminating, project-based course" serving as the "pinnacle of the academic experience" for undergraduate students at the Cullen College of Engineering. Many other courses, however, still incorporate physical design elements prior to a student's senior year to prepare them for such a large academic and practical undertaking.
"We're working on acquiring more equipment so that students have all of the tools they need to succeed in fabricating the physical elements of their design projects," says Kovach. "I worked closely with design faculty leaders to put together a portfolio that advancement and corporate relations can show potential sponsors what the senior Capstone Design experience is all about and how they can get involved. They can see that there is huge value in

contributing funding to these projects: they're getting a fresh perspective from our students about how to solve their design problem, and at the same time, those students are getting invaluable industry guidance and professional learning experiences. We have multiple sponsorship levels: some organizations may provide general funding, whereas others might want to fund a particular project, and others still might want to fund a particular project while getting involved with mentoring and support for participating student teams."
"I don't go into anything thinking that I know everything," Kovach affirms. "I'm here to partner with people, to build relationships, and to see other people be successful."
In fact, Kovach's methods for designing and innovating programming options are inherently cooperative. Each step toward a potential new solution incorporates input from multiple sources – faculty members, students, and more – before a plan can be considered complete.
"We put concerted thought into planning what we'll try next based on what we know today. Then, when we try that next new idea, we see how it works and we learn from it. This is a constant cycle not of trial and error, but of thoughtful planning, acting, and studying."
It may take time for the fruits of Kovach's labor to mature, but her dedication to the undergraduate students at the Cullen College of Engineering has undoubtedly already begun shaping the future of innovation here in Houston and around the world.
"I'm really excited about the future and about what we can achieve," she says.







STUDENT SUCCESS IS ABOUT SUPPORTING OUR STUDENTS IN ACHIEVING THEIR GOALS: GRADUATING ON TIME, PASSING THEIR COURSES, GETTING THE TUTORING HELP AND SUPPORT THEY NEED, AND FEELING LIKE THEY ARE PART OF THE COMMUNITY WITHIN THE CULLEN COLLEGE OF ENGINEERING
- JAMISON KOVACH

The Cullen College of Engineering is happy to announce the hiring of 26 new faculty members in a variety of departments and roles for the 2024-25 academic year.

Ali Yousefi, Associate Professor
Yousefi earned his doctorate in electrical and computer engineering from the University of Southern California. Yousefi previously worked as an Assistant Professor at the Worchester Polytechnic Institute. His research focuses on developing methodological solutions to problems concerning neuroscience data analysis.

Andrew Nordin, Assistant Professor
Nordin has undergraduate and graduate degrees in physics and kinesiology from Lakehead University and a doctoral degree concentrating in biomechanics from University of Nevada, Las Vegas. Nordin’s research focuses on understanding human neuromotor control of dynam-

ic whole-body movements, such as walking, running, jumping, and landing.
Aaryani Tipirneni-Sajja, Associate Professor
Tipirneni-Sajja is a biomedical engineer with expertise in developing accurate quantitative magnetic resonance imaging (MRI) and spectroscopy (NMR) methods for identifying biomarkers and enabling early diagnosis and treatment monitoring of various diseases.

Anto Sam Crosslee Louis Sam Titus, Research Assistant Professor
Titus earned his doctorate in Cellular and Molecular Biology from the University of Texas at Dallas in 2016. For the past seven years, he has served as postdoctoral researcher at Southern Methodist University.

Lawrence Dooling, Assistant Professor (starting January 1)
Dooling will join the Cullen College on Jan. 1, 2025, as an Assistant Professor in the William A. Brookshire Department of Chemical & Biomolecular Engineering. Dooling earned his doctorate in Chemical Engineering from the California Institute of Technology. His research aims to elucidate mechanisms for phagocytosis of cohesive solid tumor cells by macrophages with the goal of improving the efficacy of macrophage-based cancer immunotherapy.

Sri Bala Gorugantu, Assistant Professor (starting January 1)
Gorugantu will join the Cullen College on Jan 1, 2025, as an Assistant Professor in the William A. Brookshire Department of Chemical & Biomolecular Engineering. Gorugantu earned her doctorate in Chemical Engineering from Ghent University, Belgium, in 2020. Gorugantu’s research expertise lies in chemical kinetics, reaction engineering and advanced characterization techniques.

Elzatahry brings over 25 years of academic and research expertise in nanocomposites and nanomaterials synthesis, specializing in mesoporous materials, 2D materials, and deep polymer materials processing with significant applications in renewable energy, catalysis, and biomedical fields. He received his Ph.D. in Applied Chemistry from Al-Azhar University in 2007, followed by postdoctoral appointments at Virginia Commonwealth University.

Beck will join the Cullen College on January 1, 2025, as an Assistant Professor in the Civil and Environmental Engineering Department. Beck earned her doctorate in civil engineering from the University of Illinois Urbana Champaign.

Hady Salloum, Research Professor
Salloum has over 35 years of experience in industry and academia, directing large-scale, complex research and development projects as well as field experiments and is currently responsible for leading research that spans various engineering and science disciplines. He is currently serving as the Director of Research for BTI at UH. He holds a Bachelors and Master of Science degrees and a Ph.D. in Electrical Engineering.

Marcos Gonzalez, Lecturer
Gonzalez joins the Construction Management department as a lecturer. He is a construction manager at PLW Waterworks. Gonzalez is involved in the college’s Construction Management Industry Advisory Board.

Ismael Velez, Lecturer
Velez is a seasoned Engineering Management Professional and is joining the Cullen College as a Lecturer in Construction Management. He brings extensive expertise in EPC project management within the oil and gas sector, with a proven track record of leading successful cross-functional teams. Ismael earned a Bachelor of Science in Construction Management in 2021 and a Master of Engineering Management in 2023, both from the University of Houston Cullen College of Engineering.

Lihong Zhao, Assistant Professor
Zhao earned his doctorate in materials science from University of Illinois Urbana-Champaign in 2020. For the past year, he has been a Research Assistant Professor at UH.



Faheem Ershad, Assistant Professor (starting January 1)
Ershad will join the Electrical & Computer Engineering Department on January 1, 2025, as an Assistant Professor. He earned his doctorate in biomedical engineering from Pennsylvania State University. His research projects specialize in the development of wearable/implantable bioelectronics for physiological sensing and treatment, focusing on cardiac/neural health, tissue engineering, and machine learning.
Padmavati Viswanath, Instructional Assistant Professor
Viswanath brings over 11 years of experience as a lecturer to our faculty. Viswanath comes to UH from the University of Newcastle in Australia, where she served as a Lecturer. She has secured research grants from both academic and industry sources, supervised PhD students, and published widely in international journals and conferences.

Bopardikar, Senior Lecturer
Bopardikar earned his doctorate in imaging science from the Rochester Institute of Technology in 2000. He has over a decade of experience working industry in the areas of multimedia analysis, biomedical signal analysis, and computational bioinformatics. He has also earned 6 U.S. patents.

Alae Lakraychi, Research Assistant Professor
Lakraychi accepted the position of Research Assistant Professor with the Engineering Technology Department. Previously he served as the Postdoctoral Scientist at UH.

Qin Lin, Assistant Professor
Lin comes to UH from Cleveland State University as an Assistant Professor. Lin earned his doctorate from Delft University of Technology, with research interests in machine learning, control theory, and industrial cybersecurity.

Maedehossadat Mohammadi, Research Assistant Professor
Mohammadi is an experienced researcher in chemical and bioresource engineering with over 15 years of professional experience. Mohammadi has held leadership roles in process design, operations, data acquisition, and analysis, and is highly skilled in converting lignocellulosic biomass into various fuels through biochemical and thermochemical routes.

Domenique Jones, Lecturer
Jones earned her doctorate from the University of Tennessee in retail, hospitality, and tourism management with an emphasis on retail and consumer sciences and certifications in women, gender, and sexuality and qualitative research. She has taught various undergraduate courses in retail and fashion merchandising. Her research agenda surrounds the social psychology of dress and seeking to understand the barriers of appearance for marginalized consumers.


George Tan, Associate Professor
Tan comes to UH from Texas Tech University and joins the Industrial Engineering Department as an Associate Professor. Tan received his doctorate from North Carolina State University in Industrial & Systems Engineering. His research interests are micro- and nanofabrication for tissue engineering, Biomedical design and instrumentation, and Biomimetic polymer structures. Tan recently was awarded an NSF CAREER Award for his project titled, “Capillary-Incorporated Bioprinting of Biomimetic Soft Tissue Constructs.

Nirathi Keerthi Govindu, Lecturer
Govindu earned a doctorate in Industrial Engineering in 2013 from Mississippi State University. Before joining the Industrial Engineering Department at UH, Govindu a data analyst at NRG Energy. Govindu’s research interests focus on using machine learning applications in health sciences and utilizing AI for project planning and design.

Tania Banerjee, Assistant Professor
Banerjee comes to UH from the University of Florida serving as a Research Assistant Scientist. Her main area of focus revolves around leveraging artificial intelligence and machine learning techniques across diverse applications.

Rahman comes to UH from Rice University as an Assistant Research Professor. He earned his doctorate in Fiber Science from Cornell University. Rahman’s academic interests lie in interdisciplinary materials science research, using an engineering and biology perspective to design and fabricate ‘Nature-inspired-Structures’.

Jingyi Luan, Assistant Professor
Luan comes to UH from Washington State University. Her expertise lies in biomaterials and nanomaterials for bio-sensing and bio-imaging, next-generation molecular diagnostics, point-of-care and wearable sensors.

Kelly Yi-Chun Huang, Assistant Professor
Huang joined the Cullen College on January 1, 2024, as an assistant professor in the Mechanical Engineering Department. Huang’s research focuses on investigations of the turbulent processes that drive the atmospheric surface layer and the development of novel and high-resolution sensing techniques.

Matthew Zelisko, Instructional Assistant Professor
Zelisko joins the Division of Undergraduate Programs and Student Success at the Cullen College as an Instructional Assistant Professor. Previously he worked as an Assistant Professor at Saint Thomas University. Zelisko earned a Ph.D. in mechanical engineering from the University of Houston in 2016.
BY BRYAN LUHN

Jinghong Chen, an associate professor in the University of Houston’s Cullen College of Engineering, has been named a Senior Member of the National Academy of Inventors (NAI).
The University of Houston now has 36 faculty members in the NAI.
"Today, we proudly celebrate the well-deserved induction of our esteemed colleague, Jinghong Chen, as a Senior Member of the National Academy of Inventors,” said Ramanan Krishnamoorti, vice president of energy and innovation at UH. “This honor not only recognizes Professor Chen’s achievements but also reflects the University of Houston’s commitment to groundbreaking research and innovation. Together, we are shaping a future where innovation knows no bounds.”
NAI Senior Members are active faculty, scientists, and administrators from NAI member institutions who have demonstrated remarkable innovation producing technologies that have brought, or aspire to bring, real impact on the welfare of society. They also have growing success in patents, licensing, and commercialization, while educating and mentoring the next generation of inventors.
Chen is a world-renowned expert in highspeed and radio-frequency integrated circuit technologies. He holds 10 U.S. patents and several of his inventions have been commercially licensed.
“I deeply appreciate my colleagues for their great support and inspiration on technology innovation,” Chen said. “This recognition motivates me to keep working hard on the disclosure of intellectual property, mentoring innovative students and translating our inventions to benefit society.”
Following their nomination, individuals undergo a rigorous selection process by the NAI Senior Member Advisory Committee, which is composed of elected NAI Fellows who are considered pioneers in their respective fields. This latest class of 124 Senior Members is the largest to date, representing 60 member institutions across the country. Collectively, they are named on more than 1,000 U.S. patents with 344 of those being licensed technologies and commercialized products.
“This year’s class of Senior Members is truly a testament to the outstanding innovation happening at NAI Member Institutions and what happens when the academic space encourages and celebrates invention and commercialization,” said Paul R. Sanberg, President of NAI. “We are proud to welcome these outstanding academic inventors to the Academy and look forward to supporting and celebrating them as they continue in their innovation journeys.”
I deeply appreciate my colleagues for their great support and inspiration
- JINGHONG CHEN
BY RASHDA KHAN

The U.S. Department of Defense (DoD) awarded a $5 million grant to the University of Texas Rio Grande Valley (UTRGV)led America’s Additive Foundry Consortium, which includes the University of Houston as a key partner. This is one of six grants – totaling about $30 million –to help enhance national security through community investments.
The funding will enable the consortium to undertake a $7.5 million project designed to ensure that the U.S. military has a stable supply of domestically produced, high-quality tactical alloys critical for national defense. The consortium will accomplish this by focusing on developing novel advanced manufacturing methods.
UH, located in the Energy Capital of the World, has a special advantage to contribute. Ben Xu, assistant professor of mechanical engineering and Presidential Frontier Faculty Fellow at UH, will serve as the site director of the Houston-based Demonstration Hub for the consortium. The demonstration hub will link small and medium-sized manufacturers to DoD contractors, showcase various advanced manufacturing processes, provide local
technical support to facilitate commercialization and implementation of the proposed novel technologies and help upskill and reskill existing workforce.
“Securing the supply of specialty alloys and maintaining the ability to conduct forging and casting operations are essential to producing military equipment,” Xu said. “We [the consortium] will develop and demonstrate alternative casting and forging processes by leveraging metal additive/hybrid/convergent manufacturing technologies to modernize America’s foundry operations in the Texas Coastal Plains region through advanced research, technical support, business development, and workforce training with a focus on small manufacturers.”
The consortium has an ambitious agenda. During the five-year grant period, the consortium aims to demonstrate additive casting and hybrid forging processes to 1,800 manufacturers, incubate 45 startups and pitch 30 companies. In addition, it will leverage resources of partner institutions to provide relevant workforce training and educational programs.
Other key consortium partners include the UTRGV Center for Advanced Manufacturing Innovation and Cyber Systems, UT Austin, UT San Antonio, Georgia Tech, Texas Manufacturing Assistant Center, Army Research Laboratory, America Makes, Advanced Robotics for Manufacturing, and Tooling U-SME.
This initiative is expected to benefit the TX-SGCP region, which includes Brownsville-Harlingen, McAllen-Edinburg-Mission, Corpus Christi, Houston-The Woodlands-Sugar Land, San Antonio-New Braunfels, and Greater Austin.
“Businesses and the workforce, now and in the future, need to be really knowledgeable about advances in technology –not only for optimal efficiency, but also to adapt to changing scenarios and innovate new solutions to stay competitive and secure,” said Ramanan Krishnamoorti, vice president for energy and innovation at UH. “This will benefit not only them but also the region and the nation. We have a great opportunity to revitalize American manufacturing through collaboration to foster research, innovation, and workforce development.”


Zhu Han, Moores Professor in the Electrical and Computer Engineering Department of the University of Houston's Cullen College of Engineering, is part of the 2023 Fellow class for the Association for Computing Machinery (ACM).
Han, who is also a Fellow of the Institute of Electrical and Electronics Engineers (IEEE) and American Association for the Advancement of Science (AAAS), said he was proud to be inducted with this year's class.
“They have promoted a series of innovations and their contributions have covered a wide range of fields, including algorithm design, computer graphics, network security, network search and other fields,” he said. “They have greatly enriched our daily life, work and entertainment.”
According to the ACM, Han was recognized “for contributions to distributed and autonomous management for large-scale communication networks.”
Only 68 people were selected for the honor this year, and Fellow status is granted to just 1 percent of the 110,000 members of the ACM.

Ji Chen, Professor in the Electrical & Computer Engineering Department and the Houston site director of the NSF I/UCRC Center for EMC Research, was elevated to ellow of the Institute of Electrical and Electronics Engineers, one of the highest honors of distinction provided by the organization. Chen was recognized as being one of the top researchers in the area of EM modeling and measurements for MRI device safety. Less than 0.1 percent of IEEE voting members are selected annually for the Fellow distinction.

Kaushik Rajashekara, Distinguished Professor of Engineering at the University of Houston Cullen College of Engineering, continues to receive recognition and awards on a global scale. The man who ushered in the era of electric cars, working on the General Motors EV1 in 1995 when
he was a Technical Fellow there, has been elected an International Fellow of the Engineering Academy of Japan, recognized for his contributions to power conversion and, of course, electrification of transportation.
According to the academy, Rajashekara’s election as an International Fellow specifically honors his “outstanding scientific research and scientific-technical developments in the field of energy which promote greater efficiency and environmental security for energy sources on Earth in the interests of all mankind.”
He stands among an elite group of fewer than 10 Fellows from the United States, out of a distinguished group comprising 800 Fellows and 15 International Fellows.
GÜL H. ZERZE PICKED FOR INAUGURAL JCTC BOARD

Gül H. Zerze, an assistant professor in the William A. Brookshire Department of Chemical and Biomolecular Engineering, has been chosen for a two-year term as an inaugural member for a new editorial board created by an academic journal.
The Journal of Chemical Theory and Computations (JCTC) announced the members of its new Early Career Board (ECB) in January. According to the JCTC, the initiative provides young investigators with guidance and insight into the editorial process as they pursue their independent research careers. JCTC is a peer-reviewed scientific journal, established in 2005 by the American Chemical Society, with an impact factor of 5.5 as of 2022.
YASHASHREE KULKARNI ELECTED PRESIDENT OF THE SOCIETY OF ENGINEERING SCIENCE

Yashashree Kulkarni, the Bill D. Cook Professor of Mechanical Engineering at the Cullen College of Engineering, will serve as the president of the Society of Engineering Science (SES) in 2024.
SES dates back to 1963, when it was founded as a non-profit organization, dedicated to the advancement of interdisciplinary research at the interface of engineering and science. Today, it is a vibrant society with close to 1,000 members. Two major annual activities of the SES board include hosting an annual conference that brings together people from different disciplines of engineering sciences and recognizing the accomplishments of members of the engineering science community through awards.

Associate professor of biotechnology Venkatesh Balan has been honored with the International Association of Advanced Materials' Advanced Material Award for his Department of Defense grant-sponsored work with chitin — the resilient, fibrous substance that protects the soft inner tissues of arthropods and helps mushrooms hold their shape. Chitin has the potential to address persistent needs in multiple sectors, including health and medicine and the fight against pollution, in addition to the Department of Defense's more direct interests.
TIAN CHEN’S RESEARCH PICKED FOR JOURNAL COVER
research from

the cover of Science Advances could lead to the creation of material architecture that changes its behavior based on different temperature situations.

BY ALEX KEIMIG

The Technology Division's associate professor of biotechnology Venkatesh Balan, Ph.D., was recently selected to participate in the 2024 U.S. Department of Agriculture Hispanic-Serving Institutions (HSI) E. Kika De La Garza Fellowship program.
This program is part of USDA’s commitment to advance equity in professional development opportunities as well as build a more diverse pipeline into public service and the agricultural sector.
This July, Balan will travel to Washington, D.C. to convene with the 2024 class of fellows, where they will meet with agency representatives of the USDA to learn more about the resources and opportunities available to support their students and organizations. The goal of this experience is to continually strengthen collaboration between academic and governmental leaders in support of Hispanic-Serving Institutions – public colleges and universities whose full-time undergraduate enrollment is at least 25 percent Hispanic students – like the University of Houston.
“This program exemplifies USDA’s commitment to ensuring equitable access to the department’s programs, services and resourc-
es by underserved groups," said Lisa R. Ramírez, director of USDA’s Office of Partnerships and Public Engagement.
"This fellowship is basically trying to bring in all these faculty who are already working in this space to build a network of researchers, and a research community, to see how we can do better for our minority students," Balan said.
"We're trying to stimulate our Hispanic student communities and help them explore the biotechnology opportunities available to them. I'm very motivated to help minority students to grow and achieve because it is my way of giving back to the community. Back in India, the caste system leads to a lot of suppression of minority students coming up in life. There are always barriers. I, myself, experience that in many places and how much I need to fight hard to work on overcoming those barriers."
He added, "I want to show these students that the opportunities exist. Within my capacity, experience, and educational background, I'm trying to leverage this program to bring students in and then lift them up to see the opportunities available to them." Balan's investment in local communities and his networking on the national and international scales all tie back to the same core inspiration.
"All of these things are interconnected in helping me to achieve my end goal of developing some technology with can help people come out of poverty and hunger," Balan said. "I'm working to achieve that greater vision by supporting our students and helping build relationships."
Within my capacity, experience, and educational background, I'm trying to leverage this program to bring students in and then lift them up to see the opportunities available to them.
- VENKATESH BALAN
Tomika Greer
BY ALEX KEIMIG
Assistant Professor of Human Resource Development (HRD) Tomika W. Greer has been recognized with the Excellence in Critical HRD award at this year's Academy of Human Resource Development (AHRD) international research conference in Virginia.
Her recently published textbook, Human Resource Development: Critical Perspectives and Practices (co-authored with Laura L. Bierema, Jamie L. Callahan, Carole J. Elliott and Joshua C. Collins), was also named HRD Book of the Year.
"This [Excellence in Critical HRD] award is in recognition of me, as an individual, having reached a professional milestone in building a career in critical HRD by bringing critical perspectives into my research, service, and teaching," Greer said.
Critical perspectives were not always Greer's approach of choice when it came to solving problems.
"My background is in engineering, so I'm used to a world where we work a problem, circle the answer down at the bottom of the page, and are either right or wrong,” she said. “With critical perspectives, there's not always a 'right' or 'wrong' way to do or approach something, so I was almost repelled by this concept at first.”
"I grew up with an engineer as a dad. I'm married to an engineer. I have a bachelor's degree in engineering. Human Resource Development can seem like something totally outside the scope of my engineering background, but I'm living proof that there are definite connections between engineering and HRD. HRD, like engineering, is very systematic and process-driven. We deal with human processes more so than technical processes or reactions, but it is a science."
In a unique twist of fate, Greer was a member of the awards committee that originally established the Excellence in Critical HRD award several years ago, before she even considered herself a critical scholar.
"I had no idea that I would be receiving this award one day,” she said. “This award truly solidifies my identity as a critical scholar — realizing that now I'm accepted and recognized as one and feeling a responsibility to uphold the ideals of critical HRD further. I've been recognized for this, so I want to make sure I continue to do that identity justice."
Greer's textbook is just one example of her commitment to those ideals.

"I joined the textbook project in 2020, the week before everything shut down, so we wrote most of this book during turbulent pandemic times. It was a long and very difficult period, but I think the lingering personal and societal challenges strengthened the book. There was a lot to think about in terms of critical HRD during the pandemic," Greer said. "My co-authors and I were spread across several different time zones in the UK, Houston, Georgia, and Minnesota, so we got on Zoom for a few hours once a week for a virtual writing retreat where we also encouraged each other to keep making progress on our chapters."
Collaborating during the weekly writing retreats allowed Greer and her fellow authors to bounce ideas, hone phrasing and weave their separately-written chapters into a cohesive overarching narrative.
"Our textbook is an overview of foundational activities and beliefs across the human resource development field. Each chapter is devoted to a different aspect of HRD, and the thing that makes this different from other HRD textbooks that cover the whole field like this is that we use the critical perspective: a way to look at problems or situations wherein you want to identify and rectify any inequities or inequalities in power, treatment, or access within a system," Greer said.
"We have to keep asking ourselves: yes, this may be how we do things, but is it unfairly harming some people and unfairly privileging others? We can't just take everything in life at face value. It's so important for us to ask those questions, especially if we hold the ideal of social justice somewhere within us. Asking the hard questions gives us the potential to impact change for traditionally marginalized and disadvantaged populations, which is a big part of what really draws me to this work."

BY STEPHEN GREENWELL

The Cullen College of Engineering is now part of a research effort with faculty at Keio University, Japan's most prestigious and very first private institution of higher learning, that is also meant to encourage future collaboration and young researcher exchanges internationally.
The research proposal, “Research on sensing, actuation, communication, and intelligent signal processing infrastructure for ambient intelligence,” runs through March 2029. The lead PI for Cullen is Zhu Han, Moores Professor in the Electrical and Computer Engineering Department. Miao Pan, an Associate Professor, is the co-PI.
At Keio, the PI is Tomoaki Ohtsuki, Professor of Information and Computer Science. Other collaborating institutions include Charles Stuart University in Australia, Memorial University in Canada, the Norwegian University of Science and Technology, and Queen's University Belfast in the United Kingdom.
“The goal of this project is not only to boost research collaboration among top research universities in different continents on wireless communications, sensing, networking and AI, but also promotes the exchange of young researchers between Keio University and collaborative institutions abroad, including Ph.D. students, post-doctorate scholars and early career faculty members,” Pan said.
The entire project is supported by a 500 million yen grant — roughly 3.3 million USD — from the Japan Science and Technology (JST) Agency's Adopting Sustainable Partnerships for Innovative Research Ecosystem (ASPIRE) program.

Lars Tebbe, an assistant professor of research in the Biomedical Engineering Department at the Cullen College of Engineering, has earned $90,000 in funding thanks to the Knights Templar Eye Foundation (KTEF) Career Starter Grant.
Tebbe's proposal is entitled “The clinical benefits of modulating ROM1 in switching a PRPH2-associated pattern dystrophy phenotype to retinitis pigmentosa.”
According to the project's abstract, “Peripherin2 (PRPH2) is vital for the structural integrity and function of photoreceptor cells. Mutations in PRHP2 are linked to a variety of inherited retinal diseases (IRDs), including night blindness and loss of daily vision. Recent studies found a connection between mutations in PRPH2 and the IRDs Leber Congenital Amaurosis (LCA) and
Stargardt’s disease, both developing a serious form of vision-loss in the early childhood of patients.”
“The connection of PRPH2 with those two IRDs underscores the relevance of PRPH2 as a target in the development of a gene therapy for pediatric eye diseases. PRPH2 interacts with another protein called rod outer segment membrane protein 1 (ROM1). Reduction of ROM1 levels in a mouse model carrying a disease-causing mutation in PRPH2 shifted the diagnosis from loss of daily vision to a more manageable night blindness. Thus, ROM1 was identified as target in reducing the severity of loss of daily vision caused by mutation in PRPH2.”
The grant aims to reduce levels of ROM1 by using molecules named antisense oligonucleotides (ASOs) in a mouse model carrying an IRD-causing mutation of PRPH2. The study will test whether the administration of the ASOs in eye drops will be as effective as the injection of ASOs formulated in nanoparticles.
“The results obtained in this study have the potential to develop better therapeutic options for children affected with vi-
sion-loss caused by mutations in PRPH2 and thus, increasing their quality of life,” Tebbe wrote.
The foundation is committed to support research that can help launch the careers of clinical and basic researchers focused on the prevention and cure of potentially blinding diseases in infants and children. This year, the foundation awarded 26 career starter grants – more than $2.3 million in funding. To date, KTEF has provided more than $168 million on research, education and patient care, awarding $33 million in pediatric research grant awards and $10 million in endowments at five leading ophthalmology research and educational institutions.
“I want to thank the Knights Templar Eye Foundation for giving me the opportunity to advance our knowledge of the underlying mechanisms causing pediatric eye diseases and to explore novel therapeutic approaches for those eye diseases,” Tebbe said.
Tebbe joined the University of Houston in 2019. He was previously affiliated with the Department of Cell and Matrix Biology at the Johannes Gutenberg University of Mainz in Germany.

BY ALEX KEIMIG
Supply Chain and Logistics Technology Program Director Margaret Kidd was recently featured on the cover of Breakbulk Magazine — a bimonthly worldwide project cargo and breakbulk shipping industry publication — in a surprising twist that elevated her profile piece into a major feature.
Breakbulk Magazine is published six times per year, going out to major global engineering firms, port authorities, third-party logistics firms, oil and gas firms, and other entities related to global capital projects. Kidd was initially selected to be interviewed for a story detailing her connections to and involvement in the sector.
"I had absolutely no idea that I was being featured on the cover," she said. "I was in Dubai, and I spoke on a panel at Breakbulk Middle East in February. I thought they were just doing a profile piece. They didn't tell me that it would be the front-page story. I started getting early-morning texts from friends in Europe because it launched out of London, and that's how I found out." "I guess what's ironic is that most of the supply chain and global capital projects world is very male-dominated," she continued. "This is only the second time that a woman has been featured on the cover of Breakbulk Magazine, but they’re really trying to drive this message of inclusivity and diversity."
In fact, this is the third issue in a row that women have been featured as the cover story for Breakbulk Magazine. Their sixth issue of 2023 highlighted their Women in Breakbulk conference panel and initiative, sharing commentary from over half a dozen women industry leaders on their experience in the breakbulk and supply chain

sectors, and their first issue of 2024 featured Alia Janahi, DP World's Vice President of HSE Operations in the Gulf Cooperation Council.
"When you're younger and you're thinking about the profession, it's encouraging to see women doing the job, too. Not just men. If you look at program directors of supply chain and logistics education programs in the US, they're almost all men. There are a couple of women, but even on the academic side, the field is very male dominated, so I hope that seeing this might inspire some of my students and encourage them not to let anyone get in their way. It would have been great to see this twenty years ago," Kidd said. "Global logistics is a fruitful industry."
This issue — the second of 2024 — focused in part on energy transition, which Kidd notes is of particular importance and relevance to the University of Houston and its work as a Tier 1 research university.
Dubbed a "champion for Breakbulk's [next generation]" by the publication's headline, Kidd's efforts to create and maintain educational and experiential opportunities for her students are featured prominently; she emphasizes that it's not about her being on the cover as much as it is about what her presence represents for women in the industry and for the University of Houston on the global stage.
"They don't normally put an academic on the cover of this kind of publication, but there's no question that I spend a lot of time with industry to drive value to my students," she said. "The EPC world — engineer, procure, construct — includes some major engineering firms that have their home base right here in Houston, like Bechtel and Fluor. That's really my goal: the work I do when I'm speaking at these conferences drives internships and job opportunities for our students, and my focus is to make a difference for them."
BY STEPHEN GREENWELL

A professor at the University of Houston's Cullen College of Engineering has received more than half a million in funding from the National Science Foundation to refine and streamline cooperation efforts between robotic 3D printers.
Yisha Xiang, an associate professor in the Industrial Engineering Department, is the PI for an NSF proposal, “Integrated Framework for Cooperative 3D Printing: Uncertainty Quantification, Decision Models, and Algorithms.” The $505,789 award will cover research through 2026.
Xiang's research is focused on advancing data analytics and decision-making methods for the efficiency of the novel cooperative 3D printing (C3DP) technology. According to the project's
abstract, a critical barrier to the widespread adoption of additive manufacturing (AM) technologies has been slow printing speeds, leading to excessive printing times for large parts.
C3DP utilizes a fleet of printhead-carrying mobile robots to perform printing jobs cooperatively, significantly improving scalability and reducing print time. Effective methods for operational control of these systems must consider the accuracy degradation of mobile printers, which can lead to cascading effects in product quality and production efficiency, as well as various uncertain factors in the printing process that makes scheduling for C3DP extremely challenging.
The research team identified three goals for the research:
1.) Create advanced statistical machine learning models for positional accuracy prediction of robot printers and inference of hidden conditions, facilitating timely maintenance of robot printers.
2.) Develop a suite of stochastic optimization models using dynamic chance constraints for maintenance planning, production scheduling, and collision-free routing.
3.) Validate and demonstrate the research methods through proof-of-concept experiments at their research labs, computational simulations, and collaborations with industrial partners.
Successful development of these models and algorithms will potentially transform AM into a new, ultra-efficient era of automated 3D printing.
Co-principal investigators for the research are Wenchao Zhou, an associate professor in the Mechanical Engineering Department at the University of Arkansas; and Harsha Gangammanavar, associate professor in Operations Research and Engineering Management at Southern Methodist University.
Xiang joined the Cullen faculty in Fall 2022. She earned an NSF CAREER award in 2020 for her research proposal, “Enhancing Environmental and Economic Sustainability of Additive Manufacturing-Based Remanufacturing.”

BY ALEX KEIMIG
Retailing and Consumer Science lecturer Blake Mudd was recently honored with the New Achiever Award at this year's American Association of Family and Consumer Sciences Texas (AAFCS-TX) Annual Conference.
This recognition comes hot on the heels of Mudd's installation as the conference's Vice President of Membership at last year's conference. Mudd stated it "was quite the honor" to be nominated by Human Development and Consumer Sciences Department Chair Barbara Stewart, who holds esteemed standing with AAFCS.
“Dr. Stewart is so supportive of all of us. She's our champion,” Mudd said. “She says, 'I'm going to nominate y'all for every single thing, and when I do it, I'm going to send you what I wrote and why I'm nominating you,' and that's always such sweet motivation.”
Mudd's predecessor as Vice President of Membership won this very same New Achiever award herself 25 years ago.
“That really drove home that I'm following in a lot of great footsteps here. So many of our members have been members for 30, 40, even 50 years, so in a way, this award feels like real evidence of their support and approval,” he said. “This award is almost like the reassurance that I'm doing the right thing. It's endorsement to keep going down this path, and to consider my legacy to encourage the next person who wins this award. It's not necessarily about opening new doors for me, but for me to help keep the doors open for those following me.”
When I think about every step I do, whether it's a conference presentation or answering administrative emails, I always keep in mind that I'm doing this for students.
- BLAKE MUDD
Called "full-throttle" in his pursuits by Stewart in her nomination letter, Mudd cites the importance of service and connection as key to his success.
“I'm really lucky that I have a lecturer position, which sounds ironic, because most people want to go tenure-track,” he said. “That's the goal when I get my Ph.D., but right now, I get to work with students all day, every day, and 100 percent of my workload is student-facing. When I think about every step I do, whether it's a conference presentation or answering administrative emails, I always keep in mind that I'm doing this for students. I really enjoy just the student experience and that's what I find rewarding even though it's a bit less tangible than some other outcomes. That's what I'm contributing to the field – I
hope – in addition to students' education.” He added, “We are teachers and researchers first and all of these other things second. The reason that we have our jobs is because of students. That's special. When I think about AAFCS specifically, we have people who work in extension, and people who work in high schools and universities, and people who sometimes work in non-profits, but the overall idea is that we are all serving somebody. I'm lucky that the people I serve are students. Whether our students or people in the local community, we are all passing along knowledge to others to make them better people, and I think that's important.”
“There was not one single moment that led to this award for me. This is recognition of years of involvement and service in our field.”


Elizabeth Rodwell
"I'm particularly interested in the differences in the way that this technology has been adopted in the US versus Japan because of their reputation for robotics," Rodwell continued. "They're known for their robotics, but tools like Siri or Alexa or Google Home are not well-liked or much used there, so I was curious as to why that is. I found a startup to embed myself with wherein I can watch people work and learn more about what they're doing. With this Fulbright award, I'm going to be able to really get back into that."
Rodwell is interested not only in the theoretical research, but in the potential for other applied use cases of this technology. One of these potential uses is as a tool for children in the US who are participating in speech therapy.
BY ALEX KEIMIG
BY ALEX KEIMIG
Elizabeth Rodwell, Ph.D., will begin traveling to Japan as a Fulbright Scholar to further her user experience (UX) research on the development of conversational artificial intelligence tools.
She'll be returning to undertake further field work at a Japanese company that she started working with last year. The company is developing avatar-based conversational AI tools based on GPT, which are intended to be used for language-learning. That type of human-computer interaction is exactly the topic that piques Rodwell's interest.
"I say that I'm somebody who works on technology, but not as a person who is as interested in technology as I am in people,” she said. “I'm really only interested in the technology and all the different things that have changed over the years I've been studying it insofar as I can get down into how people interact with it, their experiences of it, and what it's like to be one of the creators or makers of it.”
I'm particularly interested in
the differences in the way
that
this technology
has been adopted in the US versus Japan because of their reputation for robotics
- ELIZABETH RODWELL
"I stare at people while they do things, and then I try to build theories around that," she added, laughing. "That's really the core of what I do, because at the end of the day, I'm an anthropologist."
"I wanted to follow up on this because it's an area that hasn't been studied much: the way kids on the autism spectrum can benefit from talking to conversational artificial intelligence as part of their overall speech therapy. I'm working with them as a partner for that project as well," she said.
This particular avenue of investigation did not simply appear to Rodwell out of the blue. It's part and parcel with the unique division of time that she will be spending abroad.
"My Fulbright is unusual," she said. "I broke it into little chunks during summers instead of one full academic year because one of my kids has special needs, so I can't keep him abroad during the school year because he has a lot of services that have been very carefully scheduled and aligned here at home. I'm glad that organizations like the Fulbright are maturing to realize that complicated family situations like this do exist."
Undertaking her Fulbright research over the course of several summers also allows Rodwell to continue teaching UX courses for the Technology Division's Digital Media program, maintaining the UH UX Research Lab and supporting UX Coogs during the academic year.
BY ALEX KEIMIG

The Technology Division's Medhat El Nahas, instructional professor of Engineering Technology, has a keen eye for potential. Whether he's reaching out to industry colleagues to keep tabs on professional openings for his students or visiting Houston-area high schoolers to promote education in science, technology, engineering and mathematics, he sees opportunities to enhance his community wherever he goes.
"It's not only money that one can give to benefit their college or university. Giving back with opportunities for students – contacting friends in the industry about scholarships, internships, parttime and full-time jobs – can also make a big difference,” he said. “The worst scenario is that someone replies and says no. I am not shy, even when it comes to hearing no. if I help find even [one student a] job each year, I still consider that success.”
In 2023, El Nahas was recognized by Galena Park Independent School District and its Board of Trustees for his outstanding dedication to and support of their district and high schools. Of particular note is his participation with the North Shore High School Center's "Men of Greatness" club, with whom he discussed the future and opportunities of engineering educations and careers. "I decided to visit as many schools as possible. I gave myself an assignment to visit at least one new high school per semester –Houston ISD this time, maybe Humble ISD next time, then maybe Richmond and then Sugar Land, and so on – so that I could truly get to know the students coming to our university," said El Nahas. "My usual presentation is an introduction to engineering education. It explains the difference between, for example, mechanical engineering and mechanical engineering technology, and the
difference between engineering and science. I also push to hear their thoughts – why do we need engineers? What are they doing today? I can have a concurrent meeting with someone who is 10,000 miles away from me. I can watch the World Cup at the same it's being played on the field from my cell phone, no matter where I am. How have engineering and technology impacted our lives, and how can our lives impact engineering and technology?"
El Nahas earned his Ph.D. from Cullen's Mechanical Engineering Department in 2011, and he has served as a senator for the University of Houston's Faculty Senate since 2017. He doesn't undertake these efforts for the public recognition or acclaim.
"When I was a student, I didn't have many opportunities to, for example, get somebody from the industry to come in and speak to us, so I decided from my first day as a professor to establish this collaboration with both my industry contacts and with high school students,” he said. “I can be the connection between all of these groups. My mission here is to promote engineering education and ensure that the next generation is aware of their options – their opportunities… I've been able to reach out to so many people and build a very special trust with them. I'm not coming to take anything; instead, I'm building a relationship."
The one thing he does take away from these interactions is insight.
"What could improve my teaching style? What do I need to know about these incoming students? What do they need to know about the industry?" he said. "We learn from one another."

BY STEPHEN GREENWELL
The Cullen College of Engineering recognized the hard work and efforts of its entire workforce at the 2023-24 Faculty and Staff Excellence Awards, held during the Faculty-Staff Meeting in May.
THE W.T. KITTINGER TEACHING EXCELLENCE AWARD
This award is traditionally the highest teaching award given in the college that recognizes outstanding teaching and service to the students. Michael Nikolaou, a professor in the William A. Brookshire Chemical and Biomolecular Engineering Department, earned the honor this year.
THE WILLIAM A. BROOKSHIRE TEACHING EXCELLENCE AWARD
This award recognizes faculty who demonstrate an unwavering commitment to exemplifying the highest levels of teaching excellence inside the classroom. This year's winner was Xuemei Chen, instructional associate professor in the Mechanical Engineering Department.
THE TEACHING EXCELLENCE AWARD
This year, eight people received a Teaching Excellence Award, which recognizes outstanding teaching and service to students:
• Aaron T. Becker, associate professor in the Electrical and Computer Engineering Department
• Daniel Floryan, assistant professor in the Mechanical Engineering Department
• Olivia Johnson, assistant professor in the Technology Division's Human Development and Consumer Science Department
• Dimitrios Kalliontzis, assistant professor in the Civil and Environmental Engineering Department
• Kyung Jae Lee, associate professor in the Petroleum Engineering Department
• Mehmet Orman, associate professor in the William A. Brookshire Chemical and Biomolecular Engineering Department
• Elizabeth Rodwell, assistant professor in the Technology Division's Information Science Technology Department
• Jinsook Roh, assistant professor in the Biomedical Engineering Department
This highest honor is afforded to a member of the faculty for research. The award recognizes career excellence in research, teaching and service. Gangbing Song, Moores Professor of Mechanical Engineering, is this year's winner.
THE RESEARCH EXCELLENCE AWARD

This award recognizes faculty for their outstanding research contributions:
• Xingpeng Li, assistant professor of Electrical and Computer Engineering.
• Craig Glennie, Civil and Environmental Engineering, and the P.I. and director of the National Center for Airborne Laser Mapping, and
• Megan Robertson, professor of the William A. Brookshire Chemical and Biomolecular Engineering, and associate chair for Faculty Development and Inclusive Excellence.
• Xuqing (Jason) Wu, associate professor in the Information Science Technology Department.
THE ANDREA PROSPERETTI RESEARCH COMPUTING STUDENT AWARD
This year's winner recognizes a person that has demonstrated a singular achievement in the broadly defined topics of scientific computing and data science. This year's recipient is Ayush Gupta, a graduate student of Gül Zerze, assistant professor in the Chemical and Biomolecular Engineering Department.
THE CAREER INNOVATOR AWARD
This award recognizes a track record of successful efforts by faculty in innovation and entrepreneurship during their career at UH. This year's awardee is Yan Yao, Hugh Roy and Lillie Cranz Cullen Distinguished Professor in the Electrical and Computer Engineering Department.
THE YOUNG INNOVATOR AWARD
This distinction recognizes efforts by students or postdocs in innovation and entrepreneurship at UH. Jian Chen, a Ph.D. student in the Mechanical Engineering Department, won this year's award.
FACULTY SERVICE EXCELLENCE AWARD
This award recognizes contributions to the mission and vision of the Technology Division and not just on the number of committees served. This year's winner is Tony Liao, associate professor in the Information Science Technology Department.
INSTRUCTIONAL FACULTY AWARDS
This honor recognizes exceptional teaching by instructional faculty and lecturers beyond what is characteristically expected of tenured or tenure-track faculty. Mequanint Moges and Burak Basaran, both instructional professors in the Technology Division's Engineering Technology Department, earned the distinction this year.

BY BRYAN LUHN
The U.S. Department of Energy (DOE) Office of Science has chosen three University of Houston graduate students for its prestigious graduate research program.
UH Ph.D. candidates Farzana Likhi, Caleb Broodo and Leonard Jiang were among 86 students from 31 states selected for Office of Science Graduate Student Research (SCGSR) program which provides worldclass training and access to state-of-theart facilities and resources at DOE national laboratories.
“I commend these outstanding students on their selection to the DOE’s Graduate Student Research program,” said Sarah Larsen, vice provost and dean of the UH Graduate School. “This recognition is a testament to their hard work and dedication to pushing the boundaries of science and to our commitment to fostering excellence in research and innovation.”
Broodo, a second-year Ph.D. candidate and former Cougars basketball player
whose research focuses on heavy ion nuclear physics, will work at Brookhaven National Laboratory in New York. He also earned an undergraduate degree in electrical and computer engineering from the Cullen College of Engineering.
“I’m excited to investigate the properties of extreme matter created in high-energy collisions through the speed of sound,” Broodo said. “Such a parameter has the potential to enhance our working knowledge of the physics of extreme matter, ultimately giving us new insights into the behavior of the interior of neutron stars and the universe itself just microseconds after the Big Bang.”
Likhi, a fourth-year Ph.D. candidate in the materials science and engineering program, will do her research on microelectronics at Oak Ridge Laboratory in Tennessee.
“For this specific project, I will conduct a systematic fundamental study on the filler-matrix interfacial dynamics based
on variable domain structured polymer utilizing broadband dielectric spectroscopy (BDS),” Likhi said. “This study will advance microelectronics to meet our nation’s need for compact and efficient power electronics while serving as guiding principles for designing hybrid solid-state capacitors for next generation flexible electronics.”
And Jiang, a third-year Ph.D. candidate in materials science and engineering, will head to Argonne National Laboratory in Illinois to work on research related to electrochemistry.
“My research is on the utilization and characterization of organic molecules as electrochemically active electrode materials for different systems,” Jiang said. “Compared to the electrode materials that are currently commercialized, organic molecules offer major advantages such as high energy density, low cost and environmental friendliness.”
BY BRYAN LUHN

The U.S. Information Technology Collegiate Conference (USITCC) 2024 Nationals were held in Louisiana last month, and the UH Cougars triumphed in both awards and accomplishments.
UH's Future IT Professionals (FITP) organization was named the IT Student Organization of the Year, and UH students were recognized with nine other awards across competition categories such as Systems Analysis & Design, Network Design and PC Troubleshooting.
"That comes from their preparations," said instructional associate professor of computer information systems (CIS) José C. Martínez. "The last two semesters, we have really worked hard to prepare for regionals and nationals. I never take anything for granted. Before the competition, I hold workshops and help the students that are going to attend run through all sorts of details and material reviews, example problems and discussions, so that we know we're prepared. This time, I engaged other faculty to do the same thing — to help prepare students according to their specialties. Next semester I'm going to engage everybody that I can."
The benefits of attending USITCC are not limited only to students.
"As faculty, we were there not only to support and facilitate the trip," said assistant professor of computer information systems Peggy Lindner. "I got the chance to interact with other Information Technology instructors and we discussed ongoing challenges regarding engagement of students and integration of AI into our curriculum."
"I think USITCC offered great opportunities for our students to demonstrate directly what they learn in CIS courses," Lindner added. "They also had the chance to talk to students from other programs about careers."
"At USITCC, they do a sort of roll call where they have everyone do some sort of cheer or school chant, so we did 'Whose House?', and it was very encouraging because we were the loudest of the group," said participant and CIS junior Haley Heyman. "Then right after that they went into the student organization awards, and we found out that FITP had won IT Student Organization of the Year. It was very uplifting, especially after all of the travel time to get there."
"Our progression [at USITCC] has been so great that every year we get to take home more awards, but this year was so groundbreaking because we tried a lot of different things with regard to connecting students to professors [with particular specialties] to prepare," agreed participating CIS junior and Future IT Professionals (FITP) Vice President Sai Todupunoori.
Martínez also looks forward to further reinforcing the importance of student experience and growth over focusing on bringing home the most awards.
"Where is the trade-off?" he mused. "Some students are so good that they're going to be winning awards as sophomores in only their third semester of school. That means that they still have two or three more years before they graduate, and that can be six semesters – six competitions – that they can go and keep succeeding at.”
“What I am thinking is that I'm more interested in providing these experiences to as many students as possible. That means that we're not going there to win every single time, which is okay, because it means that the greatest number of students get the opportunity to have that experience, to gain that confidence and be made ready for the industry. That's my goal. I would prefer to have more prepared students to go into the industry than to win the most awards."
Martínez maintains high hopes for his students, both at future conferences and in their transitions to professional industry positions.
"I am very confident in the value of our students and our program. We are showcasing their skills, their practical experiences and all of their knowledge, but at the same time we are developing leadership skills in how to organize, execute plans, and make things happen."

BY BRYAN LUHN
The University of Houston was crowned national champions at the 2024 ITA National Wheelchair Tennis Championships, the premier competition in all of collegiate wheelchair tennis.
In a remarkable display of skill, determination and teamwork, the No. 3 Cougars defeated No. 1 San Diego State in a three-hour match at the USTA National Campus in Lake Nona, Florida, to win the school’s first wheelchair tennis national title.
UH’s team of Jose Arriaga and Nicholas Tijerina won the doubles match 8-6 and Arriaga clinched the title with a 6-2, 5-7, 10-6 victory in the first singles match. Tijerina earned his B.S. in Mechanical Engineering from Cullen in 2023, and he is currently pursuing his M.S. in Aerospace, Aeronautical and Astronautical Engineering with a concentration in Control Systems and Dynamics.
“We were kind of the plucky underdogs, and there were a lot of institutions ranked ahead of us early in the season,” said Michael Cottingham, associate professor of health and human performance and director of Adaptive Athletics at UH. “But Nick and Jose had a really great run and it’s exciting for us to have that first national championship.”
Head Coach Gabriel Gutierrez, a UH alumnus whose leadership Cottingham says was instrumental in the team’s success, won ITA Wheelchair Coach of the Year.
During the season, UH competes against other universities, but most of its matches are played in USTA and ITF tournaments against non-college athletes, so there are opportunities for both students and non-students with disabilities to compete. In the national championships, teams were allowed one student and one non-student athlete. For UH, Tijerina was the student player while Arriaga, a Houstonian who has been training with the UH program for several years, was the non-student player.
“This championship not only solidifies our position as elite competitors, but it shows prospective student-athletes that they can get top-notch tennis training along with great academics and an incredible college experience,” Cottingham said. “We want to bring in strong students who represent UH well and go on to have successful careers after tennis.”
Cottingham hopes the victory propels the UH program to new heights. Soon there will be a fully funded scholarship for one student-athlete through the One Step Closer Foundation. And this summer, UH will host the ITF Junior Camp of the Americas, a showcase for the best 11–18-year-old wheelchair tennis players in the world.
“Our goal is to be a destination program, and with the resources we’re putting in place, I’m excited for the future,” Cottingham said.
BY STEPHEN GREENWELL

A doctoral student in the Civil and Environmental Engineering Department at the Cullen College of Engineering has been selected for a fellowship from a competitive pool of applicants.
Abdulrahman Salah is a Ph.D. candidate mentored by Dimitrios Kalliontzis, an assistant professor in the CEE Department. Salah earned the American Concrete Institute (ACI) Foundation's Fellowship for the 2024-25 academic year.
“I was so excited about winning the scholarship,” he said. “Receiving this fellowship felt like a beam of light on the path I had chosen. I am deeply grateful for the opportunity to further my research and the trust placed in me by the ACI Foundation. This fellowship is not just a recognition of my work. It is a promise of the impact we can achieve together in the future of civil engineering. I am thrilled at the prospect of contributing to meaningful advancements in our industry.”
The fellowship comes with a $10,000 educational stipend, as well as recognition in Concrete International magazine. Salah will also be matched with a mentor from industry, and attend the ACI conventions in Philadelphia in November 2024 and Toronto in 2025.
Salah came to the Cullen College of Engineering to pursue his doctorate in Fall 2021.
“The academic environment and the great research history of UH in the field of structural engineering influenced my choice of UH for pursuing a Ph.D.,” he said. “The opportunity to work alongside Professor Kalliontzis, with his profound knowledge, combined with UH's state-of-the-art research facilities, presented a unique synergy that perfectly matched my academic aspirations and research goals in concrete technology.”
He added, “Houston’s welcoming community and my advisor’s unlimited support have made it an ideal place for my doctoral experience and fostering personal growth.”
Houston’s welcoming community and my advisor’s unlimited support have made it an ideal place for my doctoral experience and fostering personal growth
- ABDULRAHMAN SALAH
Salah moved from his home country Yemen after high school to Saudi Arabia, where he earned his bachelor's degree in civil engineering from Umm Al-Qura University and his M.Sc. in structural engineering from King Saud University. He also worked for about four years as a civil engineer before deciding to pursue his advanced degrees. Since 2019, Salah has received authorship credit on seven papers.
“I would like to merge my academic insights with my practical experience to drive forward innovation in concrete technology,” he said. “I see myself not only as a future expert in the field but also as a bridge connecting the latest research findings with practical applications in the industry.”
BY STEPHEN GREENWELL

A doctoral candidate in the Civil and Environmental Engineering Department at the Cullen College of Engineering has been hired for an internship with a national laboratory this summer.
Kripa Adhikari will work as an intern for AI/ML Models Testing at the Pacific Northwest National Laboratory in Washington from May to August this year. Her advisor is Kalyana Babu Nakshatrala, associate professor and associate chair of the Civil and Environmental Engineering Department.
"I have been working in the field of renewable energy, including geothermal
energy," she said. "My expertise lies in modeling, where I integrate concepts from continuum theories, mathematics, simulations, and machine learning perspectives. To validate our models effectively, we collaborate closely with experimentalists and field scientists from various universities and national labs."
She added, "Based on our previous work on microvascular composites, published in renowned journals like PNAS Nexus and Communications in Computational Physics, researchers at PNNL were interested in collaborating with our research group at UH. Together, we recently completed a manuscript on geothermal energy using conventional modeling tools. To further our collaborative efforts, PNNL offered me an internship. After undergoing multiple steps in the screening process, I successfully secured the internship offer."
"I aim to leverage machine learning techniques and apply them to the field of carbon capture and storage, which also involves subsurface modeling," she said.
"Our laboratory, CAML at UH, has extensive experience in subsurface modeling, and incorporating machine learning-based modeling is a recent addition to our research group. This internship opportunity will enable me to utilize my existing knowledge while also acquiring new skills in this domain after working closely with researchers at PNNL."
Adhikari has had a distinguished academic career at UH. In July, she presented research on thermal cooling after earning a travel award for the 17th U. S. National Congress on Computational Mechanics (USNCCM). In November, a paper by her and Nakshatrala about temperature regulation was published in PNAS Nexus. This year, she was also named to the inaugural cohort of UH-Chevron Energy Graduate Fellows.
My experience at UH has been truly remarkable, offering numerous opportunities in novel research fields
"My experience at UH has been truly remarkable, offering numerous opportunities in novel research fields," she said. "None of this would have been possible without the guidance and support of my advisor, Dr. Nakshatrala, for whom I am immensely grateful. Additionally, I express my gratitude to our collaborator at PNNL, Dr. Maruti K. Mudunuru, an earth scientist, for his invaluable guidance. Finally, I am thankful for all the motivation and support from my family and friends. "
Adhikari plans to defend and graduate in the spring of 2025.
- KRIPA ADHIKARI
BY STEPHEN GREENWELL

An engineering student completing his doctorate at the University of Houston was honored by being selected for a Research Internships in Science and Engineering (RISE) Professional summer research internship in Germany.
Yuan Zi is studying in the Electrical and Computer Engineering Department at the Cullen College of Engineering. He was chosen for a 2023 summer internship, and completed it with the industrial AI team at the ABB Corporate Research Center in Germany, under the mentorship of Ralf Gitzel, Ph.D.
“It was an incredible experience, working alongside domain experts and data scientists who had dedicated years to solving complex problems,” he said. “This internship provided me with a multitude of positive experiences that I hold close to my heart.”
According to Zi, he used his background in geophysics and seismic data processing and applied it to the field of non-invasive monitoring for medium voltage switchgear.
“This allowed me to predict the health of mechanical devices, which is crucial for predictive maintenance. What made this experience particularly special for me was the discovery of a new
behavior that illuminated a more physically explainable research direction for predictive maintenance monitoring methods,” he said. “It was a true eureka moment, and I felt an immense sense of pride knowing that my work was contributing to the advancement of the project.”
The trip was also positive from a work-life balance for Zi. He is a native of China and came to states to study at UH. Being exposed to the work culture of Europe was a new and welcome experience for him.
“I appreciated the European work-life balance and the inclusive environment that embraced people from diverse backgrounds. In Germany, we were encouraged to take two normal days off each month, in addition to public holidays, for much-needed rest,” he said. “This not only promoted a healthy work-life balance but also allowed me to explore other European countries during long weekends.
When it came to choosing a place to pursue his doctorate, Zi identified several factors important to him.
“The deciding factor that led me to join the University of Hous-
ton was the availability of a full scholarship,” he said. “Pursuing a Ph.D. is a significant commitment, and the financial aspect cannot be overlooked. Having a scholarship that covered my expenses allowed me to fully focus on my academic and research endeavors without the burden of financial concerns.”
He added, “My choice to join the University of Houston was driven by a combination of the city's strong ties to the energy industry, the program's compatibility with my background, and the critical financial support that allowed me to pursue my doctoral studies with dedication and peace of mind.”
Zi encouraged both graduate and undergraduate students to apply for RISE internship opportunities. It has led to networking opportunities, as well as professional and personal development for him.
My choice to join the University of Houston was driven by a combination of the city's strong ties to the energy industry, the program's compatibility with my background, and the critical financial support that allowed me to pursue my doctoral studies with dedication and peace of mind
-YUAN ZI
“Being part of the RISE Professional program opened doors to the DAAD alumni portal, connecting me with previous award recipients. This platform gave me exclusive opportunities to participate in community ideathons and receive mentoring from those who had already navigated similar paths. It was a remarkable way to tap into a network of experienced individuals, further enhancing my personal and professional development,” he said.
“In essence, my summer internship with ABB was an unforgettable adventure filled with enriching experiences, both professionally and personally. It allowed me to make meaningful contributions, expand my horizons, and connect with a global community of professionals, and for that, I am immensely grateful.”
BY STEPHEN GREENWELL
A doctoral student at the Cullen College of Engineering has been recognized with a NASA Silver Achievement Medal, for outstanding leadership and innovation of the biomedical and countermeasure hardware selection and flight certification processes.
Kimia Seyedmadani, a biomedical engineering student pursuing her doctorate, received the honor during a ceremony in December. Her advisors are Metin Akay, Founding Chair and John S. Dunn Endowed Chair, and Yasemin Akay, Instructional Associate Professor. Together, they lead the Neural Engineering and Informatics Laboratory in the Biomedical Engineering Department.
The award caught her totally by surprise.
“I was happy and stunned,” she said. “I am an Iranian immigrant with a diverse engineering background, and here I was, receiving one of the highest honor governmental medals, for impact to the field of Bioastronautics. Many people had to nominate me, from my management and above, for me to be recognized. I was very humbled by the support of my family, mentors and, most of all, my team, and I remembered them all, even those who were no longer with us.”
Seyedmadani earned her B.S. followed by her M.S. in Bioengineering and Biomedical Engineering from Arizona State under the guidance of Vincent Pizziconi, an associ-
Kimia Seyedmadani [center], a biomedical engineering student pursuing her doctorate, received the NASA Silver Achievement award during a ceremony in December.

ate professor in the School of Biological and Health Systems Engineering. She also earned her M.S. in Aerospace Engineering and Bioastronautics from the University of Colorado at Boulder under the guidance of James Voss, a former NASA astronaut as well as an AIAA Fellow and Smead Aerospace scholar-in-residence.
Seyedmadani's diverse educational background correlates with the different things asked of her when it comes to her NASA work at the Human Research Program. It is responsible for human exploration, safety, the longevity of crew, and bringing back learned and human research on Earth for increased quality of life.
“I am a spacebiomedical engineer, meaning my work directly translates to the design, development and certification of bio-
medical and countermeasure hardware for using crew members in space,” she said. “Before my job at NASA, I worked in the medical device and diagnostic industry for 10 years and developed more than 50 medical devices. I am very intrigued by translational research and innovation. Many of my applied research was in that area.”
“NASA recognized me for my ability to translate my previous knowledge to expedite the flight certification process without compromising quality control by augmenting an existing memorandum with the Food and Drug Administration (FDA) and using existing information in the commercial industry. ”
While Seyedmadani had a diversity of knowledge prior to being hired at NASA, she wanted to continue the journey of higher education to be able to transform her work. She chose UH specif-

ically because of Metin and Yasemin Akay’s mentorship and vision.
I have known them since my undergraduate degree, and I have always appreciated Dr. Metin Akay's interest in innovation, entrepreneurship and increasing healthcare globally
-KIMIA SEYEDMADANI
“I have known them since my undergraduate degree, and I have always appreciated Dr. Metin Akay's interest in innovation, entrepreneurship and increasing healthcare globally,” she said. “I hoped that under their direction, I could continue my work at NASA, continue my independent research, and achieve my doctorate.”
She has conducted research across human subsystems, from musculoskeletal to neuro-cognitive and now at UH neuro-ocular, which she said allowed her to have an appreciation for the human complex adaptability and plasticity across subsystems.
Seyedmadani also added that creativity and inspiration come from anywhere and from anyone, for those who seek knowledge. She considers a key for her success to be perseverance and hard work. Therefore, she encourages everyone to "Never, Ever Give Up!"

BY ASHLEY V. VELAZQUEZ
Students from the Supply Chain and Logistics Technology (SCLT) program in the Technology Division of the Cullen College of Engineering proudly received recognition for their hard work on port and maritime student research posters at this year’s Port of the Future Conference, held at the University of Houston from April 2 to April 4.
The conference served as a great networking opportunity for leaders in the maritime industry to listen to keynote speakers, share experiences and connect with other professionals in their field. In addition to the conference, the International Propeller Club hosted the 2024 Student Research Poster Contest, where students were encouraged to create a poster based on the key issues and themes for this year’s conference.
Topics for the competition included Port Infrastructure 4.0, Port Development,

Port Energy and Sustainability, Decarbonization and Alternate Fuels, Terminal Operations, Port Workforce, Development, Intermodal Connectivity, Port Security and Cybersecurity, and Enhancing the Port Eco-System.
While the majority of submissions were from UH students, other participating universities included Ho Chi Minh City International University, American Military University, University of Texas Arlington, among others.
The agenda included keynote speakers from the Port of Houston and former U.S. Ambassadors, along with panels and conferences composed of presidents, CEOs and other industry specialists from leading maritime institutes.
Kevin Velazquez, an SCLT student from UH, was one of the authors of “Shielding the Supply Chain: New Cybersecurity Measures,” a poster that focused on a new Executive Order regarding port cybersecurity laws.
“This was a great opportunity to showcase my skills and abilities,” he said. “I participated in the Breakbulk Research Poster Competition last year and realized I enjoy participating in these events. So, when the opportunity to create a poster for the Port of the Future came up, I said yes.”

Not only was this event a great way for students to use their skills, but it also left an impact on some students, an accomplishment they will remember throughout their undergraduate careers.
“When I received this award, I felt extremely grateful,” said Technology Leadership and Innovation student Maryam Alhagi, who also worked on the same poster. “Being a first-generation student has motivated me to reach for academic achievement such as this. This will no doubt stand out as part of my academic journey in the future.”

The team worked long hours to create their poster as they decided to change their topic two weeks before the due date, working on it even when a difficult family emergency arose for two of the team members during this time. The team saw the project to its end despite adversity.
Events like the Port of the Future conference are invaluable to UH students, since it allows them to showcase their hard work, knowledge and skills from their courses. They provide opportunities to help students build up their resumes, polish their skills, contribute to the industry, network with professionals, and proudly represent their university.

BY STEPHEN GREENWELL


For Theophilus Kaaya, a proud University of Houston alumnus, his connection to his family was an important consideration when it came to initially picking a college, especially since he would be acclimating to the United States from Uganda.
“I came as an international student, and my first two siblings came before me. They went to Texas Southern University,” he said. “I was interested in mechanical engineering or something else involving engineering. It had to be engineering, which TSU didn't have at that point.”
It was a combination of the programs offered and the proximity to his family that combined to make UH an attractive school for his undergraduate degree.
“UH had my major, mechanical engineering, and it was close to TSU, where my siblings had gone before,” he said. “Compared to other universities in the Houston area, it was also more affordable.”
Kaaya earned his doctorate from UH in 2023, and he is now a propulsion engineer at Boeing. Throughout his educational journey, Kaaya said he has relied on his family, community, and God for support.
“Family bond is important. We're raised to grow together as a family and to work things out together as family, so that has helped a lot in my journey,” he said. “They have been there in my down moments when I'm feeling low, and they've been there in my high moments. That has helped temper and handle any challenges that I've faced throughout my academic journey. It's important, and I treasure it very much.”
Once he was enrolled at UH, Kaaya said that the staff at Learning Support Services (LSS) — now known as LAUNCH — were vital to his success. He later worked as a tutor for LSS for majority of his undergraduate as well.
“Down there we had Dr. Laura Heidel, and Mr. Kenneth Williams, they were my supervisors,” he said. “They equipped us with all the resources we needed to be successful, not only as tutors, but also as students. They made the learning process and stay at school memorable and enjoyable. Every time I finished my work, I had to go down to the tutoring center and help students. I love teaching and tutoring, and that helped me build my social, negotiation and teaching skills.”
As part of his studies, Kaaya had to take history courses, which he noted with a laugh that he initially wasn’t looking forward to. But now, he recognizes their importance.
“I didn’t like history that much at first. The fact that I had come to college, and they told me I had to do history, again, I was thinking of going back,” he said, laughing. “My sister told me to think of the big picture. What do you actually want? And that helped me put things in perspective. History was just two semesters, and that would be it, but eventually, when I attended the classes, I started enjoying history. And to this day, I can see how history does actually affect and informs engineering. We may not think of it that much, but it actually plays a vital role, even when you’re solving problems.”
Kaaya earned his mechanical engineering degree from Cullen, but elected to continue at the college, earning his master's degree and doctorate as well. The financial aid offered by the school and the strides in improving the research environment were key in his decision. The university achieved Tier One status in 2011, which was reconfirmed in 2016.
“They did offer some scholarships that I took opportunity of for my Bachelor's level, and they also offered me a scholarship for my master's degree. That allowed me to come back and do the first year of my master's before I switched to the Ph.D.,” he said. “The Ph.D. offered the Graduate Tuition Fund and departmental scholarships that helped cover most of the tuition, and it also allowed me to get a monthly stipend that covered my expenses for my day-to-day living.”
When asked if he had advice for current students, Kaaya stressed the importance of reaching out to others for support.
“There is no need to fear faculty and staff. They are there to help us succeed,” he said. “Make friends and make the memories count. This is one of the best times you will have in your academic journey. Be resilient, determined, and focused on your goals. It is easy to get distracted, but having accountability buddies and remembering the reason you are going to school will keep you on track. Use as many opportunities available as possible. You never know what might come of them.”
Make friends and make the memories count. This is one of the best times you will have in your academic journey.
-THEOPHILUS KAAYA
BY STEPHEN GREENWELL

When Marissa Seshadri was looking at ways to earn a master's degree, it was important for her that the school offered flexible learning programs. After all, she already had a full-time job. That is ultimately part of why the University of Houston was an appealing option for her, and she received her M.S. in Construction Management this past spring.
“I chose UH to pursue my Master's for a few reasons,” she said. “UH’s Construction Management program is ranked #3 in Texas. The online program option offers amazing flexibility for full-time working professionals such as myself, and the CM program maintains key relationships and industry partnerships with construction firms throughout the Houston area.”
She added, “I knew that by attending UH, I would be equipped with the right skills and connected to the right people to be competitive and successful in today's construction industry.”
Seshadri highlighted the support she had received from her friends and family, as well as her workplace, as reasons why she thrived in her academic career.
“My most significant academic influences would absolutely be my family — my husband, my mother, my sister and my late father,” she said. “They have always emphasized the importance of education and how it is the key to success. Everything I do is for them. I would also be remiss if I didn't mention the encouragement and support I received from my mentors and team at Turner & Townsend as well. Their unwavering reassurance and belief in my potential kept me going.”
Thinking of her time at UH, Seshadri said that meeting Renu Khator, chancellor of the University of Houston System and president of the flagship UH campus, was something she would never forget and one of her most cherished memories.
“She is a such a kind and inspiring woman who has shattered barriers and led UH to become a top-tier institution in academics, research and athletics,” Seshadri said. “Participating in a President’s Roundtable was a once-in-a-lifetime opportunity that I’ll never forget, especially because Dr. Khator truly listened to our perspectives as students. I'd encourage any student — If you ever receive an email asking you to apply to be considered for a President's Roundtable, do it! You won't regret meeting her.”
Seshadri had three pieces of advice for students, regardless of their level, looking to maximize their UH experience.
“First, network relentlessly. Attend career fairs, join student organizations, connect with industry professionals. Relationships matter and now is the perfect time to start building those relationships.”
“Second, seek mentorships. Professors, advisors and alumni — they’re your allies. Don’t hesitate to seek guidance from those who are best equipped to help you.”
“Finally, you need to find a balance. Academics are important, but also learn when and how to prioritize self-care. Your mental health matters just as much as your grades. The years go by fast, so have a little fun!”



Your investment in the UH Cullen College of Engineering helps support our mission to provide students with an exceptional learning experience that inspires top research from our faculty and prepares our graduates to shape the future of innovation.
PLEASE SCAN THE QR CODE AND DONATE TODAY TO THE CULLEN COLLEGE OF ENGINEERING!
BY STEPHEN GREENWELL

When Ruth Posada walked across the stage on May 11 to accept her master's degree in Information Technology Project Management, it will be in recognition of her dogged perseverance that included a fight against multiple forms of cancers.
“I received my health diagnosis of cervical and stomach cancer in the middle of applying for the master's program,” she said. “I was overwhelmed as my oncolo-
gist recommended for me to wait after surgery and completion of treatments. However, those close to me know that if I am told no, I will just do the opposite. It was no surprise to those who know me that 'no' was never an option for me. I have always been a very determined individual, and once I commit to something, I will fulfill that commitment.”
The effort has been harrowing at times
for Posada, but she said that having multiple items to focus on and care about — her family, the pursuit of her degree — helped in her recovery.
“Honestly, if I did not have school to focus on, I am not sure I would have been so successful with my treatments. School allowed me to push myself harder and it gave me a breath of fresh air when doctor appointments were tough,” she said.

“In December of 2022, I was rushed to the hospital due to internal bleeding post-surgery complications from my stomach surgery. I had finals that week and right before surgery, my words to my doctor were I need to recover fast, I have finals in less than 48 hours. I knew the professors would work with me, but I had too much pride to request an extension. Needless to say, I was on a hospital bed taking finals. Obviously, this is not how I had pictured my UH experience to be like, but I believe there is a reason for everything. I hope my story motivates someone who is struggling or feels defeated.”
Posada wasn't alone in her fight, as she identified her husband Wes and her children, Jakki and Anthony, as supporting her extensively.
“There were times I was tired and exhausted, and the side-effects of brain fog made it very challenging for me to focus, but on these days I was frustrated, they comforted me with words of encouragement,” she said. “My kids were giving me the advice I would give them during difficult times and there was no way I was going to give up. My kids reminded me of the promise I made to my grandmother when I was little, that I would reach every goal I set my mind too because all she ever asked from me was to obtain a college education.”
Posada is a first generation college graduate. She received her undergraduate degree from the University of Phoenix. She decided to pursue her degree while in the process of adopting a child.
“Being a first generation graduate, I had no one who could guide me through the process, so I had to select a university that had online courses because I had to juggle work, traveling for work, and my family,” she said. “During this time of my life, we were going through an adoption process here in Houston, and during the adoption process I realized I wanted to break cycles in my family. The only way to do this was to get an education, so my
kids had better opportunities. The University of Phoenix was the university that fit that criteria at that time.”
While she wasn't able to get her bachelor's degree at UH, she identified it as a school she knew she wanted to attend one day.
“Once I made the decision to obtain my master's, I knew UH was on top of the list,” she said. “After a lot of research, I was glad that UH provided the master's program that I was interested in, Technology Project Management. I was impressed by the curriculum and the way the program was designed to apply to real world projects.”
At UH, she identified two professors as being significant, positive influences on her progress — Dennis L. Sherman, instructional assistant professor of Technology Project Management, and Lila Carden, assistant professor of Technology Project Management.
“Both of them have always gone above and beyond, to be there for me and guide me through this journey,” she said. “Every lesson taught by both of these professors and the passion they have for teaching and wanting each student to be successful is why I am overwhelmed with appreciation for all they have taught me through this academic journey. Listening to their own challenges throughout their careers and the success stories they have shared with me only motivated me to make it to the end.”
Carden said she was happy to support Posada’s pursuit of her degree, noting that her determination was something she noticed immediately.
“As a part of Ruth’s network, I focused on her entire experience of achieving student success, which included instruction, leading, coaching, mentoring, motivating and listening,” Carden said. “During my first conversation with Ruth about her capstone project topic, I listened to her as she shared about being a woman in
the oil and gas industry and about the challenges of a Hispanic woman working in project management in information technology.”
“My response to Ruth was, ‘If I had listened to the words people said to me, I would not be teaching today. Instead let it bring fire in you.’ The fire that Ruth displayed was evident by selecting her professional work project as her academic capstone project as well as by utilizing her motivation to implement teamwork, leadership, communication and project management skills to meet the requirements of the course. Ruth's aforementioned attributes and skills are pivotal for her advancement in the STEM workforce.”
Posada added that her classmates and teammates refused to treat her any differently when they learned about her health issues, which she was grateful for. Her graduation cap is focused on all of these positive influences.
“My cap quotes, 'I wanted to quit but then I remembered who I was doing this for,' and it has pictures of me with my family and my grandmother,” she said. “I am also thankful to my family and my siblings for their unconditional love and support and to many of my friends who have followed my story and have cheered me on.”
With her degree in hand, Posada said she is open to a range of new opportunities.
“Earning my master's is an achievement that I never thought was possible, so as I prepare for graduation, I am full of pride and joy,” she said. “I am confident this degree will open doors so I can become a full project manager. I eventually hope to reach my goal of a PMO, either within my organization or another organization. I want to also focus on mentoring others who want to return to school and perhaps don't know where to start or those who just need a support system through their journey.”

BY ALEX KEIMIG

Some might say that the writing is on the wall when it comes to digital security. For Technology Division alum Prathibha Muraleedhara, who earned her master's degree in cybersecurity at the University of Houston, it might be more apt to say that the writing is in the cloud(s).
Having completed her bachelor's degree in telecommunications at BMS Institute of Technology in India, Muraleedhara spent several years working with KPMG India and Paladion Networks, where she handled application security architecture review.
"My passion for cybersecurity was growing, and I really felt how important this area is and the demand for it. Every company needs a cybersecurity team, right? So, I thought, let me pursue my education further and get a formal degree in cybersecurity. That's when I enrolled at the University of Houston."
Muraleedhara cites the comprehensive and multidisciplinary coursework — from PEN testing and SCADA security to risk assessment and project management — as instrumental in preparing her to formally advance her career. She mentioned that professor Arthur Conklin had a particularly positive influence on her.
"Professor Conklin, in particular, was very inspiring,” she said. “[My graduate education] gave me a good foundation to build
on, and it prepared me to go and face the professional world outside. Even the project management skills I learned are helping me to work as a manager now. So many of the topical courses too, like PEN testing, were very hands-on. It wasn't just trying to understand theory by reading a book. The class was very practical, with labs set up to help us break into networks and act like attackers to better understand how they think, how they break into systems, and how we can fix them."
During her time with what was then the College of Technology, Muraleedhara completed a summer internship with HPE in Austin, Texas. She also contributed to the university's Cybersecurity Team operations. In both experiences, her work focused on detecting and identifying network vulnerabilities, bolstering intrusion prevention, and studying incoming traffic to help identify potential threats.
In short: she worked multiple critical angles to keep the black hats out.
"That was a great learning experience for me," she said.
Muraleedhara now works for Stanley Black & Decker, and recently published a chapter, "Threat Modeling and Risk Analysis for Cloud Deployments", in Analyzing and Mitigating Security Risks in Cloud Computing. The book aims to emphasize the significance of educating cloud customers about the potential threats and security risks associated with the cloud-based services as well

as relevant tools to help organizations safeguard their cloud environment.
Her chapter identifies various security concerns that can occur due to misconfiguration, providing an in-depth explanation of the methodology used for cloud architecture threat modeling and an actual threat modeling assessment of an application hosted via AWS.
"Just because your application is hosted in the cloud does not automatically make it secure," Muraleedhara said. "It's still exposed to threats. It's the responsibility of both the cloud providers — like AWS, Azure, and Google Cloud — as well as the people host their applications in the cloud to consider security. Ninety-five percent of the security of cloud-based applications lies with the customers who post them.”
"If you're renting a house," she continued, "you trust the builder, but you still need to have security controls like cameras, lock your doors, and keep your windows closed."
As her career continues, Muraleedhara hopes to encourage more women to pursue educations and careers in cybersecurity, which she describes as a "male-dominated domain."
"I've been working with Women in Cybersecurity (WiCyS) — attending conferences, mentoring, and serving as a tech ambassador … I'd really like to mentor and help other women who are also coming up in this field," she said.
LIFETIME ACHIEVEMENT AWARD


Frank C. Adamek, P.E. (MSME ’75) President of Adamek Engineering & Engineering Technology Solutions, LLC
Tommy Cooper, P.E. (BSEE ’74, MSEE ’81) Founder of Cooper Consulting Service (CCS)
DISTINGUISHED ENGINEERING ALUMNI AWARD


Eliza Paul, P.E., (MS ’88) Texas Department of Transportation (TxDOT)
Dr. Abdeldjelil Belarbi, Ph.D., P.E. (TX, MO), F.ACI, F.SEI, F.ASCE, F.IIFC
Hugh Roy and Lillie Cranz Cullen Distinguished Professor University of Houston Cullen College of Engineering
EXCELLENCE IN LEADERSHIP AWARD

Urmi Prasad Richardson (MSBE ’95) President EMEA at Thermo Fisher Scientific
DISTINGUISHED YOUNG ENGINEERING ALUMNI AWARD

William Q. Walker, Ph.D. (Ph.D. ‘96) Chief Technology Officer, KULR Technology Group

The Cullen College of Engineering’s Spring Class of 2024 Commencement ceremony was held in May. More than 1,000 engineering and technology graduates took their long-awaited walk across the stage at the Fertitta Center to receive their degrees.












More than 600 attendees enjoyed a fabulous day on campus that connected the energy sector with the Cullen College of Engineering and Technology Division. The community event brought together alumni, faculty, students and professionals for networking, food and fun.







The legacy of kindness, hard work and generosity left behind by UH engineering alumnus William A. Brookshire† (BSChE '57) continues to live on at the Cullen College, where hundreds of undergraduate students receive significant support for their education through Brookshire scholarships.
2023-2024 recipients of the Brookshire scholarships gathered for a Luncheon in Brookshire’s honor at the UH Hilton in March. At the Luncheon, scholarship recipients took turns sharing how the scholarship has helped them personally and professionally.



The Cullen College held the 10th Annual Women in Engineering Celebration on March 7. The event funded by distinguished alumna Cynthia Oliver Coleman, P.E. (BSChE ’71). The event was held at the UH Hilton and honored its annual Rising Star Awardee, given to a graduating female student the highest GPA. This year’s Rising Star Award went to Quynh Nguyen, an engineering data science master’s student.








More than 50 digital media seniors gathered at the University of Houston at Sugar Land for DigiFest, a portfolio presentation event held each semester to bring together students, alumni and area industry professionals for networking and employment opportunities.
The event allows students to distill years of hard work toward a degree in digital media into the very best of their works for display.




A celebratory contingent of cougars took over city hall on the afternoon of Tuesday, June 4, 2024, as the Houston City Council issued a proclamation for Cullen College Day. The proclamation and Cullen Day as a great burst of momentum to lead into the next major fundraising effort for the College — The Cullen Gala, which was held in October at the Hilton Americas Downtown Houston.







View more photos online at www.flickr.com/photos/cullencollege/albums

Today, is it invention or innovation? The University of Houston presents this series about the machines that make our civilization run, and the people whose ingenuity created them.
First, Invention: Who invented the airplane? We credit the Wright Brothers. But what about Brazil’s Santos Dumont? Well, the Wright brothers really did make the first successful flight. But, with so many limitations! They catapulted it from rails. Then it flew in a straight line for under a minute.
Four years later, Santos Dumont made several clumsy attempts to build an airplane. Then he succeeded with his Demoiselle series. They took off from the ground. They had directional control. They flew a lot longer. They were far more advanced.
Let’s look at the two machines: The first Wright Flyer was a big biplane with a water-cooled engine. No landing-gear. The Demoiselle was a small monoplane with an air-cooled engine and wheels. The two had so little in common. That’s because both were inventions – brand new creations. Neither was merely innovation. Inno-vation means making better versions of something that exists.
But innovation had to follow: The Wright Brothers went to work. They began innovating upon their invention. Now they built an airplane they could sell to the US Army. And Santos Dumas? He fell ill and quit inventing.
Innovation is now the more popular word. It’s less dangerous. But we have to improve upon the things we invent.
Think about civilian airliners, the DC-3, built in 1935, set the mold for modern passenger planes. It bristled with new inventions. But airliner forms have evolved in small steps ever since. They still keep much of the DC-3’s form today. No more Wright Brothers or Santos Dumont inventions. Mainstream airliners still advance mostly by innovation – to this very day.
But our move into space! That’s another story: So much radical invention! We still look for stable forms upon which we can safely innovate. Orbiting stations, space telescopes, land-to-space vehicles! We’re still inventing so many new forms. Of course, innovation has to follow each of these forms. But, as I write today, we still have to invent new space hardware.
My work as an experimentalist often


meant inventing new apparatus. So, I can tell you. Inventing is such fun. But here again, innovation must follow. Any new apparatus reveals ways in which we have to improve it.
Look at any new invention, Benz’ first automobile, for example, just a seat with three wheels and a steering stick! But then invention slowly gave way to innovation with smaller and smaller changes. Today our cars have a few basic forms. And these forms change less, from year to year.
So let us sing the praises of both invention and innovation. We cannot survive without both. Which is better? It really comes down to where in the drama of creating new things, we choose take our place.
I’m John Lienhard, at the University of Houston, where we’re interested in the way inventive minds work.
John
Lienhard


The Engines of Our Ingenuity is a nationally recognized radio program authored and voiced by John Lienhard, professor emeritus of mechanical engineering and history at the University of Houston and a member of the National Academy of Engineering. The program first aired in 1988, and since then more than 3,000 episodes have been broadcast. For more information about the program, visit www.uh.edu/engines.
Watch this edition of Engines Of Our Ingenuity on our YouTube Channel:
@UHEngineering



